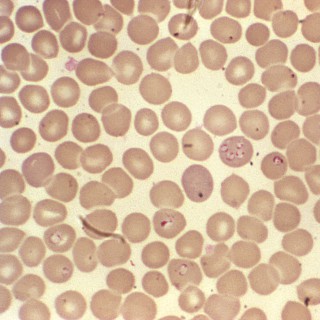

Podcasts about Babesia
- 103PODCASTS
- 280EPISODES
- 52mAVG DURATION
- 5WEEKLY NEW EPISODES
- Jun 23, 2026LATEST
POPULARITY
Best podcasts about Babesia
Latest news about Babesia
- Ticks and the growing threat beyond Lyme disease NaturalNews.com - Mar 17, 2026
- 60 Degrees Pharmaceuticals Announces Detection of Babesia Infection in 24 Percent of Patients ... GuruFocus New Articles - Dec 29, 2025
- Human Babesiosis Caused by Babesia venatorum, Russia, 2024 Emerging Infectious Diseases Journal - Aug 19, 2025
- In Vitro Monitoring of Babesia microti Infection Dynamics in Whole Blood Microenvironments Wiley: Advanced Science: Table of Contents - Aug 11, 2025
- Spermidine is a key polyamine required by intracellular parasites for survival within host erythrocytes | Science Advances AAAS: Science Advances: Table of Contents - Jun 18, 2025
- Case study: Bartonella, Babesia pathogens can be a cofactor in complex neurological illnesses The Medical News - Mar 23, 2025
- Coinfection Fails to Affect Babesia Outcomes Medscape Medical News - Oct 31, 2024
- Babesiosis Is On The Rise — Here’s What To Know About The Potentially Deadly Disease MadameNoire - Oct 16, 2024
- After Wetland viruses, Babesiosis raises alarm in US: Symptoms, causes, treatment & more News-Economic Times - Sep 11, 2024
- Prevalence and molecular detection of <i>Babesia microti</i> in rodents in Southeastern Shanxi, China PLOS ONE - Jul 3, 2024
Latest podcast episodes about Babesia
The Diagnosis Your Doctor Is Too Afraid to Make You've been depressed, exhausted, foggy, and in pain for years. You've tried the antidepressants. You've done the workups. Everything comes back normal. But you are not normal. You are not well. And nobody can tell you why. What if it's Lyme? Dr. Terri sits down with Pamela Cipriano, DNP, APRN — a functional medicine and Lyme disease specialist who trained under one of the country's leading Lyme experts — to have the conversation most conventional doctors won't. From a teenager who spent two years in a psychiatric facility before anyone thought to test him for Lyme, to the political reality that doctors in Texas can be reported to their board just for making the diagnosis — this episode exposes why one of the most common tick-borne diseases in the country is also one of the most misdiagnosed. The symptoms of Lyme overlap almost perfectly with depression, anxiety, hormone imbalance, autoimmune disease, and neurological disorders. That's not a coincidence. It's a diagnostic crisis. If you've been chasing answers and hitting walls, this episode is for you. What you'll discover: Why the standard two-tier Lyme test misses the majority of cases and what patients should be asking for instead [12:23] How Lyme can hide in the body for decades before a stressful event triggers full-blown symptoms [06:09] The teenager misdiagnosed with a psychiatric disorder who spent two years institutionalized before anyone tested him for Lyme [20:19] Why doctors in Texas risk board complaints just for diagnosing Lyme disease and what that means for medical freedom [08:18] How Lyme symptoms overlap with hormone deficiency, creating a compounding diagnostic blind spot [31:15] Co-infections like Bartonella and Babesia: what they are, why most doctors aren't testing for them, and how they change the treatment picture [28:15] The connection between Lyme, mold toxicity, and chronic illness and why the best providers look at all of it together [33:47] How to find a provider trained to properly test and treat Lyme when only a few hundred specialists exist in the entire country [39:14] You are not crazy. You are not anxious. You may just not have the right diagnosis yet. The Dr. Terri Show is presented by EVEXIAS Health Solutions.Learn more and find a provider near you at evexias.com Connect with Dr. Terri:
How a Missed Lyme Diagnosis Destroyed a Family (And What We're Doing to Stop It Happening to Yours)
My guest Nicole Bell is the CEO of Galaxy Diagnostics and author of What Lurks in the Woods. She came to this work after her husband's Lyme disease — along with co-infections Bartonella and Babesia — was misdiagnosed as early-onset Alzheimer's. He passed away in 2022. In this episode, we talk about why the standard Lyme test misses so many people (hint: it's 30-year-old technology that relies on antibody detection from a pathogen that actively suppresses your immune system), what co-infections like Bartonella and Babesia actually do to the brain and body, and how Galaxy Diagnostics is using urine-based antigen testing and digital PCR to find what older tests can't. We also get into the myths that keep people from getting the right diagnosis — including why only 14% of Lyme patients get the classic bullseye rash, why Lyme is present in all 50 states, and why finishing a round of doxycycline doesn't mean you're in the clear. If you or someone you love is dealing with unexplained mood changes, cognitive decline, chronic fatigue, anxiety, or joint pain — this conversation is worth your full attention. For the complete show notes, links and transcripts, visit inspiredliving.show/249
#85 – Lyme and Co-Infections: A Hidden Driver of Gut and Chronic Symptoms with Dr. Crane Holmes
Could Lyme disease or co-infections be contributing to gut symptoms that aren't improving?In this episode, Dr. Crane Holmes and the turd nerds break down Lyme disease and common co-infections - including Bartonella and Babesia - and how they can impact not just the gut, but the entire body. We explore how these infections can present as chronic digestive issues, brain fog, inflammation, and multi-system symptoms that don't respond to typical treatments.In this episode, we discuss:What Lyme disease actually is (and why it's often misunderstood)The role of co-infections like Bartonella and BabesiaHow these infections can affect the gut, nervous system, and immune systemWhy symptoms often go beyond digestion (brain fog, fatigue, joint pain)When to consider Lyme or co-infections in complex casesChallenges with testing and diagnosisTreatment approaches, including antimicrobials, herbs, and biofilm supportThis episode is for anyone dealing with chronic gut symptoms, unexplained inflammation, or complex health issues that haven't improved with standard approaches.Music provided by Blue Dot.
EP235: Inside CIRS Lab and the Evolving Science of Biotoxin Illness - Christian Navarro-Torres, PhD
Episode 566: When Lyme Disease Steals Your Identity: How Poetry Helped Jasmin Perdomo Heal
What happens when chronic Lyme disease takes away your health, your confidence, and even your sense of self? In this deeply emotional and inspiring episode of the Tick Boot Camp Podcast, Jasmin Perdomo shares her powerful 12-year journey through chronic Lyme disease, Bartonella, Babesia, debilitating neurological symptoms, medical gaslighting, emotional trauma, and ultimately — rediscovering herself through poetry, faith, and healing. Raised in New Jersey and once a hyper-athletic young woman, Jasmin never imagined she would one day become bedridden, unable to walk without holding onto walls, crawling from her bed to the bathroom, and searching desperately for answers no doctor seemed able to provide. But through unimaginable suffering came transformation. Jasmin opens up about: Living years undiagnosed with Lyme disease Severe neurological Lyme symptoms including vertigo, memory loss, facial paralysis, and heart complications The emotional toll of chronic illness and divorce Her experience with aggressive antibiotic protocols and Herxheimer reactions Why detoxification, nervous system healing, spirituality, and creativity became essential parts of her recovery How poetry became her lifeline during the darkest moments of her journey This conversation is raw, validating, and hopeful for anyone navigating Lyme disease, chronic illness, trauma, or identity loss. In This Episode You'll Learn Jasmin's Early Lyme Disease Symptoms Jasmin describes how unexplained fatigue, tachycardia, heart palpitations, vertigo, ringing in the ears, slurred speech, and neurological symptoms slowly overtook her life while living in Puerto Rico. The Reality of Medical Gaslighting Like many Lyme patients, Jasmin spent years searching for answers while being misdiagnosed, dismissed, and prescribed medications that failed to address the root cause of her illness. Chronic Lyme Disease and Emotional Trauma The episode explores the connection between stress, trauma, emotional suppression, nervous system dysregulation, and chronic illness progression. How Poetry Became a Healing Tool While bedridden, Jasmin returned to writing poetry — something she loved as a child — and discovered that creative expression became a powerful emotional detox and survival mechanism. Buy Bittersweet Body: a Poetic Memoir, Jasmin's debut poetry book, inspired her life's mission: to illuminate the invisible in a visible world. The Importance of Detoxification and Nervous System Healing Jasmin discusses the therapies that helped her most, including: Sauna therapy Binders Meditation Faith and prayer Journaling Acupuncture Gentle movement Emotional release through writing Learning to Receive Help One of the most moving parts of the interview centers around Jasmin's struggle with independence, vulnerability, and learning how to accept support from loved ones during her healing journey. Key Takeaways From Jasmin Perdomo's Lyme Journey Healing from Lyme disease requires addressing the physical, emotional, and spiritual body. Detoxification can be just as important as antimicrobial treatment. Creativity and self-expression can become powerful healing tools. Nervous system regulation matters in chronic illness recovery. You are not weak for asking for help. Healing is possible — even after years of suffering. Quotes From This Episode “Poetry saved my life. It gave me mouth-to-mouth resuscitation when I couldn't breathe.” “When my body became a stranger, writing helped me remember who I was.” “You are not weak for asking for help.” “Healing isn't just physical. It's emotional, spiritual, and deeply personal.” About Tick Boot Camp Tick Boot Camp is a Lyme disease advocacy platform dedicated to helping people liberate themselves and others from Lyme disease through education, validation, community, and hope. Through powerful conversations with patients, doctors, researchers, and healers, Tick Boot Camp reminds listeners that they are not alone — and that healing is possible.
Ticks, Lyme Disease & Everything You Need to Know with Dr. Alexis Chesney
Lyme disease and tick-borne illness can be a scary thing... and, even scarier - they are on the RISE. Sometimes we know we've gotten exposed - other times, not so much - and we can go undiagnosed for years ... With ticks expanding in numbers and areas across North America, more and more people find themselves dealing with everything from flu-like symptoms and joint pain to fatigue, brain fog, neurological symptoms, and chronic illness that can be difficult to explain. SO - how do you know if a tick bite has become something more serious? What are the early Lyme disease symptoms to watch for? And what should you do if you suspect you've been exposed, whether recently or years ago?Today, I sit down with Lyme disease expert and naturopathic physician Dr. Alexis Chesney, author of Preventing Lyme and Other Tick-Borne Diseases. She has got us COVERED, and after the episode, you will feel much better equipped to deal with what's going on now. We're covering:What Lyme disease actually is and how it's transmittedWhy Lyme disease cases are increasing across North AmericaThe truth about the classic bullseye rashEarly warning signs of Lyme disease that are often overlookedHow Lyme can affect the brain, nervous system, energy levels, and moodWhy symptoms can come and go, making diagnosis difficultThe testing limitations that can lead to missed diagnosesThe difference between acute Lyme disease and long-term Lyme-related illness (and treatment!) Why some people struggle for years before getting answersCommon tick-borne co-infections including Babesia and AnaplasmosisWhether Lyme disease can be fully treated—and why there is more hope than many people realizePractical prevention strategies to reduce your risk of tick bitesThe importance of finding a practitioner who understands both the science and complexity of tick-Tick & Tick-Borne Illnesses ResourcesDr. Chesney's Website: https://www.dralexischesney.com/Dr.Chesney's Book: click hereFind a practitioner: International Lyme and Associated Diseases SocietyCanadian resource for ticks, photos & education - https://etick.ca/Test a tick you find for potential diseases - https://geneticks.ca/Canadian Lyme disease Support - https://canlyme.com/ & https://www.lymehope.ca/Big thanks to our sponsor - ITL HealthTo learn more and explore products - click here!
36 Doctors Missed It: Amy Kurtz on Lyme Disease, Medical Trauma Brain & Healing After Chronic Illness
What happens when your body starts to heal, but your mind is still trapped in survival mode? In this episode of hol+, Dr. Taz sits down with Amy Kurtz, certified health coach, patient advocate, speaker, and author "But You Look Fine", for a powerful conversation about chronic illness, Lyme disease, medical gaslighting, nervous system trauma, and what it really means to heal.Together, they explore Amy's 20+ year journey through unexplained pain, chronic symptoms, misdiagnosis, and the search for answers that finally led to a diagnosis of late-stage neurological Lyme disease and co-infections. Amy shares what it was like to be told her labs were normal while knowing something was deeply wrong in her body, and how years of invalidation shaped her relationship with her health, her identity, and her trust in herself.Dr. Taz and Amy also discuss why so many people live in the “gray zone” between sick and well, especially when symptoms are invisible, complex, or hard to explain. They unpack why normal labs do not always mean optimal health, why Lyme disease can be missed for years, and how chronic illness can impact relationships, career, emotional safety, and the nervous system.This conversation offers a grounded and hopeful look at what happens after illness, when the body may be improving but the mind and nervous system are still bracing for the next crash. Amy introduces her concept of Medical Trauma Brain, or MTB, which describes the anxiety, hypervigilance, fear, and survival patterns that can remain after chronic illness, cancer, stroke, chronic pain, or any major health crisis.If you're listening to this and thinking, “I know something is off in my body, but I don't know where to start,” join the Circle here:
Why You're Tired All the Time: Mold, Metals, and the Hidden Drivers of Chronic Fatigue
What if the reason you're tired, foggy, and burned out has nothing to do with stress or sleep? Most high-performing men assume their fatigue, brain fog, and inflammation come from doing too much. But there's another conversation happening in functional medicine that most doctors miss completely. Dr. Torrie Thompson is the founder of Meraki Wellness Center in Austin and specializes in mold, heavy metals, environmental toxins, and Lyme disease. She's spent over a decade helping people figure out what's actually wrong when their labs look "normal" but they feel terrible. This one hits close to home for Jon. He's been dealing with Lyme, Babesia, and chronic inflammation for the better part of a decade. His CRP (a key inflammation marker) has averaged 90 for the last 10 years, with his most recent test coming in at 127. Tori told him on the podcast it's the highest she's ever seen, by a lot. If you've ever wondered why you feel off and your doctor keeps telling you everything looks fine, this conversation is for you. In This Interview: → Why mold is the most common hidden driver of chronic fatigue and brain fog in men today → The three foods that hold the most mycotoxins (and why you can't see or smell them) → How to actually test your body and your home for mold (and the testing companies to avoid) → The difference between binders that help and binders that hurt → Why standard doctors miss Lyme disease and what to do if you suspect you have it → The order of operations: why you have to clear mold and metals before treating Lyme → Why chelation can wreck your health and what to do instead → How to spot misaligned incentives when a doctor pushes expensive weekly IV drips → The cheapest, most overlooked tools for healing (PEMF, grounding, breathwork, sleep) → Why your toxic bucket size determines how sick you get and how fast you recover This Conversation Is For You If: → You're exhausted, foggy, or inflamed and your bloodwork keeps coming back "normal" → You've been to multiple doctors and nobody can tell you what's wrong → You suspect mold in your home or your body and don't know where to start → You've been bitten by a tick at some point and never felt the same since → You're a business owner whose energy is the engine and you need it back online Next Step: If this conversation made you curious about what might be sitting in your body or your home, Dr. Torrie and her team work with clients across the country. You can learn more about her practice and the work she does at drtorriethompson.com. Connect With Dr. Torrie Thompson: Website: drtorriethompson.com Instagram: instagram.com/drtorriethompson
Episode 121: Why Lyme Disease Is Exploding - Coinfections, Natural Remedies & The Vaccine Controversy
Lyme disease cases are skyrocketing across North America and many people are suffering with chronic symptoms for years without answers. In this episode of Wholistic Living, we dive deep into Lyme disease, coinfections like Bartonella and Babesia, chronic inflammation, biofilms, nervous system symptoms, proper Lyme testing, and holistic remedies. We also discuss why tick populations are increasing, when ticks are most active, why Lyme disease is often missed by conventional testing, and the controversy surrounding chronic Lyme disease and Pfizer's Lyme vaccine development. If you struggle with fatigue, brain fog, joint pain, anxiety, histamine intolerance, autoimmune symptoms, or mystery illness, this episode is a must-listen.Equip Grass fed protein: www.equipfoods.com/MARLA60 Day Gut Reset ($200 OFF) - https://checkout.teachable.com/secure/1716725/checkout/order_52y48hdz?coupon_code=SECRETOFFER
315: Resiliency Radio with Dr. Jill: Hidden Drivers of Chronic Illness - Inside the MSIDS Model
In this episode of Resiliency Radio with Dr. Jill, Dr. Jill Carnahan welcomes Dr. Richard Horowitz, one of the world's leading experts in chronic illness and tick-borne disease, to discuss the groundbreaking science behind the MSIDS model and its implications for conditions ranging from Lyme disease to Alzheimer's. Dr. Horowitz shares revolutionary findings connecting chronic infections, inflammation, environmental toxins, gut dysfunction, and immune imbalance to persistent disease. He also discusses a surprising breakthrough involving Alzheimer's biomarkers and chronic Lyme treatment using his innovative dapsone protocol. This powerful conversation explores how addressing the root causes of inflammation and chronic illness may transform the future of medicine and offer hope for patients struggling with complex, unresolved health conditions.
Lyme, Alpha-Gal & Co-Infections: A Functional Medicine Approach | Podcast #476
Lachlan Onegin-Ward | Lyme Disease in Australia: Misdiagnosed, Dismissed, and Fighting Back
What happens when your country's medical system refuses to believe you have the disease that's destroying your life? In this episode of Integrative Lyme Solutions, Dr. K sits down with Lachlan Onegin-Ward, a marine biologist and wildlife conservationist from Australia who contracted Lyme disease after being bitten by 17 ticks on a snake-spotting trip south of Sydney. What followed was a years-long battle not just against Bartonella, Rickettsia, and Babesia — but against a medical system that handed him antacids instead of answers. Lachlan shares the raw reality of fighting Lyme disease in a country that officially denies its existence, navigating a healthcare system that left him bedridden, seizing, and unable to move his arms — all while spending tens of thousands of dollars chasing a diagnosis. He opens up about the neurological relapse triggered by COVID, the PTSD of living with an invisible illness, losing close friends who couldn't understand what they couldn't see, and the grassroots mission he's now on to make sure no other Australian has to go through this alone. Key Takeaways: 0:00 Introduction 3:00 17 tick bites, one wildlife trip 8:10 Australia's medical system denies Lyme exists 13:20 Triple co-infection: Bartonella, Rickettsia, and Babesia 18:00 COVID triggers seizures after 11 seizure-free years 25:00 The financial toll of chasing treatment in Australia 30:30 Podcasting to fill the awareness gap 34:00 Invisible illness and the friends who disappeared Schedule a Free 15-Min Phone Lyme Consultation at The Karlfeldt Center: 208-338-8902 Resources: Lyme Disease Association of Australia - https://www.lymedisease.org.au/ Tick Science Alliance - https://ticksciencealliance.au/ IGENEX - https://igenex.com/ Let's Get Aussie Wild / Corona and Lyme Podcast (Spotify) - https://open.spotify.com/show/0xRfQ3zKvuivkgtBEiFuxf Medical Disclaimer: This content is for educational purposes only and is not intended to diagnose, treat, cure, or replace professional medical advice. Always consult your physician or qualified healthcare provider regarding any medical condition or treatment decisions. ____________________________________WORK WITH DR. KARLFELDT:The Karlfeldt Center offers the most cutting-edge and comprehensive Lyme therapies available. To schedule a Free 15-Minute Discovery Call with a Lyme Literate Naturopathic Doctor, contact us at:
Episode 562: Pediatric Lyme, Autism Regression, PANS/PANDAS & Root-Cause Healing | Dr. Somer DelSignore
In this powerful in-person interview at the Tick Boot Camp studio, Matt Sabatello sits down with Dr. Somer DelSignore, DNP, a board-certified pediatric practitioner specializing in Lyme disease, tick-borne co-infections, PANS/PANDAS, autoimmune and neuroimmune disorders, autism-like regression, and congenital tick-borne illness. This episode is essential listening for parents who have been told to “wait and see,” families who have seen multiple specialists without answers, and anyone trying to understand how infection, inflammation, immune dysfunction, and nervous system imbalance can impact a child's brain and development.
510. Dr. Stephanie Rimka :: What Big Pharma Doesn't Want You to Know
Dr. Stephanie Rimka is a pioneering clinician who authored the book, "Receive: The Dance of Feminine Power." Learn more at https://drrimka.com EPISODE SUMMARY BELOW: 1. Vision for Treatment Islands Ambition to build residential centers on multiple islands Preference to remain near the United States and in jurisdictions allowing gun ownership 2. Challenges with International Patients and Systems Difficulties treating patients from Australia and Canada Systemic obstacles to providing care across borders 3. COVID-19 Era Reflections and Medical Discourse Early preparedness with peptide therapies and supportive protocols -- At the pandemic's onset, certain clinicians organized protocols incorporating peptides (e.g., thymosin alpha-1), nicotine, methylene blue, and adjuncts like ivermectin and hydroxychloroquine to support immunity and nutrient delivery, leveraging prior peptide therapy experience. Belief that the pandemic response was misleading and coercive Censorship and platform restrictions -- Recounting bans and throttling on Instagram, TikTok, and Facebook, resorting to coded language (e.g., "cupcake") to avoid content moderation and experiencing extended live bans. 4. Social Media Enforcement and Pharmaceutical Influence Allegation of coordinated reporting by Eli Lilly -- Dr. Rimka says Instagram notified her that Eli Lilly reported her account, coinciding with actions against peers. She speculates that microdosing education threatened sales by reducing dosing volume. Selective enforcement and inconsistent standards -- Frustration is expressed over perceived preferential treatment of similar content by others and retroactive flagging of archived posts, reinforcing a sense of targeted suppression. 5. Regulatory Changes in Peptide Therapy Historical context and global research base Reclassification and access restrictions post-COVID -- Key peptides (e.g., TA1) became difficult to source after regulatory changes limiting compounding pharmacies. Clinicians turned to research-use-only and international sources, creating delays and uncertainty, which Rimka attributes to pharmaceutical efforts to limit widespread peptide use. Shift toward FDA approvals and evolving legal landscape 6. Regulatory Reclassification, Patents, and Natural Substances Peptides are naturally occurring and should not be restricted Pharma patents delivery systems/binders to capture markets 7. Pharma Influence and COVID-19 Coordination Claims Early warnings from contacts in China -- Dr. Rimka cites late-2019 warnings from contacts in Hong Kong/Shanghai who moved to Singapore and ceased WeChat communications, interpreted as signals of impending danger. Pharma's dominant role over government -- Assertions that pharma influences U.S. policy and suspect foul play in COVID-19's origins, drawing parallels to alleged bioweapon narratives involving Lyme disease and alpha-gal syndrome. 8. Intent Behind Global Response to COVID-19 Population control and compliance -- Mass vaccination and public health measures were designed to control and desensitize populations, testing compliance via mandates and social cues. Desensitization to tracking and bio-integrated technologies -- Warn of normalization of biometrics, implanted chips, and digital credentials, eroding autonomy and reshaping identity. 9. Vaccination Schedules, Immune Claims, and Endocrine Concerns Modern immunization schedules are excessive -- The interlocutors argue current infant vaccine schedules are unprecedentedly large compared to past generations. Rejection of autoimmune disease concept Vaccines and environmental endocrine disruptors -- Vaccine components and environmental chemicals (BPA, phthalates, microplastics) may influence sexuality and identity, citing animal studies and extrapolating to human exposures. 10. Nanotechnology, Frequencies, and Neurofeedback Potential for nano-chips/robots to alter physiology -- Dr. Rimka references public claims of nanotechnology capable of modulating cellular function and suggests undisclosed uses may exist, potentially via injections or environmental exposure. Brain manipulation and external frequency influences -- As a neurofeedback practitioner, Dr. Rimka describes modulating brain states via EEG-guided training and hypothesize that external infrastructures (e.g., 5G towers) could emit localized pulses affecting sleep, fatigue, and headaches. 11. Autism, Vaccine Injury, and Institutional Trust Correlation between vaccines and neurotoxicity -- The conversation frames vaccination as a high risk, referencing vaccine injury claims and the existence of a Vaccine Court, attributing neurotoxic effects to schedule components. CDC and FDA as misinformation sources 12. Personal Safety, Loss, and Public Pressure Denial of suicidality and acknowledgment of pressure -- Dr. Rimka confirms she is not suicidal, reflecting on past fears during heightened public controversy and the burden of advocacy when her child was young. Partner's death and suspected vaccine link Practitioner deaths and mentor loss -- A period of suspicious deaths among functional health practitioners, including her mentor, Dr. John Hicks, amplifying her sense of risk in the field. 13. Vaccine Lot Variability and Experimental Control Claims Variable vaccine lots and possible placebos -- Some vaccine lots may have been placebos, implying controlled experimentation and differential risk among recipients. 14. Peptides and Early Pandemic Protocols TA1, nicotine, methylene blue, ivermectin, and hydroxychloroquine -- Dr. Rimka details clinician-driven "stacking" strategies combining TA1 with nicotine and methylene blue, alongside ivermectin and hydroxychloroquine, to enhance immune support, nutrient delivery, and reduce dosages during shortages. Public awareness of peptides was limited at the time. 15. Lyme Disease, Alpha-gal, and Non-Vaccine Strategies Lyme and alpha-gal as engineered threats -- Dr. Rimka characterizes Lyme disease as man-made with multiple vectors and views alpha-gal syndrome as unprecedented and possibly engineered, linking observed field anomalies to concerning patterns and anticipated vaccine rollouts. System optimization and aggressive post-bite protocols -- Recommended approaches include immune modulation, readiness with specific products, and rapid "killing and binding" after bites. CellCore Biosciences protocols spanning 10–12 months for chelation and pathogen elimination are endorsed, with guidance to work with trained clinicians. Electromagnetic devices and mitochondrial charge -- Bob Beck protocol devices (e.g., SOTA) and frequency-based tools to raise cellular/mitochondrial charge, positing cellular voltage as a fundamental determinant of recovery capacity. Practical toolkit -- Suggested on-hand items include DMSO, turpentine, ivermectin, silver, specific devices, peptides like TA1, and tinctures for Borrelia and Babesia, with an emphasis on early, aggressive intervention. 16. Public Communication, Professional Constraints, and Promotion Polarizing messaging and informed consent Tension between education and platform policy Credentials, partnerships, and book -- Dr. Rimka discusses her book, "Receive: The Dance of Feminine Power," emphasizing balanced masculine-feminine energies, honoring reception to reduce burnout, and reflections on motherhood and work. She also suggests a peptide stack (Klotho, Follistatin, Cell Factor).
308: Resiliency Radio with Dr. Jill: The Inflamed Brain – How Mold and Infections Trigger Chronic Illness
In this episode of Resiliency Radio with Dr. Jill, Dr. Jill Carnahan explores the growing science behind brain inflammation and its connection to chronic illness with Dr. Eboni Cornish. Dr. Cornish, Associate Medical Director at Amen Clinics and Treasurer of the International Lyme and Associated Diseases Society, shares how underlying inflammation in the brain can drive symptoms often labeled as psychiatric, neurological, or behavioral conditions. Together, they discuss how mold toxicity, chronic infections, gut dysfunction, hormone imbalances, and environmental toxins can disrupt brain health and lead to symptoms such as brain fog, anxiety, depression, personality changes, and fatigue. This powerful conversation highlights the importance of identifying root causes of neuroinflammation and offers hope for individuals struggling with complex chronic conditions through advanced diagnostics, functional medicine strategies, and personalized care.
Episode 560: MCAS, Chronic Lyme Disease, GLP-1 Agonists, Biofilms, and the Future of Precision Medicine — Dr. Tania Dempsey, MD
GLP-1 Agonists, MCAS, Lyme Disease, and the Future of Precision Medicine In this powerful Tick Boot Camp Podcast interview, Matt Sabatello sits down with Dr. Tania Dempsey, MD, a board-certified internal medicine physician and internationally recognized expert in Mast Cell Activation Syndrome (MCAS), Lyme disease, autoimmune conditions, and complex chronic illness. In this comprehensive conversation, Dr. Dempsey delivers one of the most forward-thinking and in-depth discussions ever featured on the podcast — connecting the dots between persistent symptoms after Lyme, immune dysregulation, biofilms, nervous system dysfunction, and groundbreaking research on GLP-1 receptor agonists as mast-cell stabilizers. This episode offers science, clinical insight, and — most importantly — hope for patients who have tried everything and are still struggling. Lyme Disease, MCAS, and Why Patients Stay Sick Why Treating Lyme Alone Is Often Not Enough Dr. Dempsey explains why many patients continue to experience inflammation, pain, neurological symptoms, and relapses even after treating Lyme disease and co-infections. According to her clinical experience, this is most often due to primary Mast Cell Activation Syndrome, not persistent infection alone. Key insight: > Lyme disease frequently acts as the trigger, but MCAS is often the driver of ongoing symptoms. Dr. Dempsey clarifies the critical difference between: Primary MCAS (pre-existing immune dysfunction worsened by infections) Secondary MCAS (rare; resolves completely once infection is treated) She notes that in decades of clinical practice, she has never seen true secondary MCAS fully resolve without ongoing mast-cell management. SOT Therapy: When, Why, and How It Works Best Dr. Dempsey provides a nuanced and experience-based explanation of Supportive Oligonucleotide Technique (SOT) for Lyme and co-infections. She addresses common criticism: One-time SOT treatments are rarely sufficient Chronic Lyme often involves multiple strains of Borrelia , Babesia , and Bartonella Her most successful cases involve: Repeated testing Sequential SOT treatments targeting specific strains Immune system support between rounds Adjunctive therapies such as herbs, antiparasitics, and mast-cell stabilization She shares a remarkable case of a young woman with severe neuropsychiatric symptoms who — after years of persistent SOT treatment combined with MCAS management — is now thriving, off psychiatric medications, and successfully completing college. Biofilms: Why They Matter in Chronic Infection Dr. Dempsey firmly states that biofilms are a critical barrier to recovery in chronically ill patients. Key points: Biofilms exist in the gut, sinuses, blood, and tissues They protect microbes from antibiotics, herbs, and immune attack Resistant biofilms may involve extracellular DNA (Z-DNA), discussed at ILADS Therapies discussed: Enzymes such as lumbrokinase and nattokinase Ozone therapy Therapeutic Plasma Exchange (TPE) for severe cases Her message is clear: if you cannot reach microbial reservoirs hidden in biofilms, infections cannot be fully controlled. GLP-1 Agonists, Immune Modulation, and Breakthrough MCAS Research GLP-1 Receptor Agonists as Mast-Cell Stabilizers Dr. Dempsey presents groundbreaking findings from her published case series: “The Utility of GLP-1 Receptor Agonists in Mast Cell Activation Syndrome” Key details: 47-patient case series Micro-dosing of GLP-1 agonists Primary medications used: tirzepatide (Mounjaro / Zepbound) and semaglutide (Ozempic / Wegovy) Unlike weight-loss protocols, Dr. Dempsey uses very low doses to target immune modulation — not appetite suppression. What GLP-1 Therapy Improved in MCAS & Lyme Patients Reported improvements included: Cognitive clarity and brain fog Chronic pain Neuropsychiatric symptoms Anxiety and depression Gastrointestinal symptoms Systemic inflammation Hormonal dysregulation In some cases, patients experienced improvement within one or two doses. Dr. Dempsey explains that mast cells express GLP-1 receptors, and activation sends a signal of safety, reducing inflammatory mediator release. Unexpected Findings: Muscle Mass and Antibody Reduction Contrary to common concerns, Dr. Dempsey observed: Preserved or increased muscle mass in the majority of patients Improved mitochondrial function and exercise tolerance Reduction in chronic antibody production (including Lyme Western Blot bands) She shares a striking case where a patient with long-standing positive Lyme antibodies saw antibody levels decline for the first time in over a decade after GLP-1 therapy — despite infection already being treated. This supports her hypothesis: > MCAS can drive persistent immune activation even when infection is no longer present. Side Effects, Screening & Who Should Not Use GLP-1s Potential side effects (usually mild): Nausea Delayed gastric emptying Occasional vomiting in sensitive patients Important clinical notes: Some patients respond better to semaglutide vs tirzepatide A small subset may require dose cycling or pulsing Antibody formation against GLP-1 drugs is a potential research focus Non-Pharmaceutical Alternatives to Increase GLP-1 Activity For patients who cannot tolerate medications, Dr. Dempsey outlines alternatives. Herbal & Supplement Options OptimumGLP Synergy (herbal blend designed to support GLP-1 signaling) Calocurb (GLP-1 supportive compound) These options may: Reduce inflammation Help stabilize appetite and blood sugar Calm mast-cell activity Diet-Based Strategies Dr. Dempsey explains why higher-protein and carnivore-leaning diets may benefit MCAS and Lyme patients: Protein and fat stimulate endogenous GLP-1 Reduced food triggers Improved metabolic stability Patients do not need to eat exclusively meat — but increasing high-quality protein intake is often beneficial. Nervous System, Trauma & Mast Cell Feedback Loops The episode explores how: Mast cells and nerves exist in a bidirectional feedback loop Chronic fight-or-flight worsens immune activation Therapies discussed: Limbic retraining programs ( Primal Trust , Gupta Program) Vagal nerve stimulation Apollo Neuro wearable Ketamine-assisted therapy Psychedelic microdosing (emerging area) Breaking the mast-cell / nervous-system loop is often essential for healing. Women's Health, PCOS & Autoimmune Illness Dr. Dempsey shares a critical insight: > In her practice, every PCOS patient also has MCAS. She explains how: Mast cells respond to estrogen, progesterone, insulin, and cortisol Hormonal fluctuations can trigger MCAS flares MCAS may underlie PMS, PMDD, endometriosis, and reproductive pain syndromes GLP-1 therapy may offer new hope for women suffering from inflammatory gynecologic symptoms linked to Lyme and MCAS. Advocacy, ILADS & The Future of MCAS Research Dr. Dempsey discusses her work with: ILADS (International Lyme and Associated Diseases Society) ISMCAS (International Society for Mast Cell Activation Syndrome) ISMCAS goals include: Funding MCAS research Educating clinicians globally Supporting patients and advocacy efforts She encourages patients to: Educate themselves Share credible research with providers Move on from doctors unwilling to listen Final Takeaway This episode redefines what root-cause medicine truly means. Healing chronic Lyme disease often requires addressing: Immune dysregulation Mast cell activation Nervous system dysfunction Hormonal imbalance Metabolic inflammation Dr. Tania Dempsey offers a roadmap — grounded in science, compassion, and innovation — for patients
Why You Need to Know About Pennsylvania's Lyme Problem
This is episode 078 of the Love, Hope, Lyme podcast. This podcast does not replace medical treatment. If you are suffering from Lyme and other tick-borne disease, please seek proper medical treatment. Pennsylvania has been called a ground zero of the Lyme disease epidemic in the United States. On this episode of the Love, Hope, Lyme Podcast, Fred Diamond speaks with two powerful advocates who are working to change that reality. Eric Huck and Amy Tiehel from the Pennsylvania Lyme Resource Network share their deeply personal Lyme journeys and explain why advocacy, education, and community support are critical for Lyme survivors and their families. Eric's story began in 2009 after a tick bite while hiking the Appalachian Trail. Despite early treatment, his health rapidly deteriorated and he was eventually diagnosed with Lyme disease along with multiple co-infections including Babesia, Bartonella, Ehrlichiosis, and Anaplasmosis. His experience navigating the healthcare system ultimately led him to help build one of the largest Lyme advocacy organizations in the state. Amy's journey began while she was living in Los Angeles. After years of debilitating symptoms, Bell's palsy, and visits to more than 25 doctors, she was finally diagnosed with Lyme disease and Babesia. Her experience with misdiagnosis and medical dismissal pushed her into advocacy so that other patients would not have to navigate the system alone. In this powerful conversation, we discuss: • Why Pennsylvania has become a Lyme disease hotspot • The mission of the Pennsylvania Lyme Resource Network • The challenges patients face with diagnosis and treatment • The mental and emotional toll Lyme takes on families • Prevention through the Dare 2B Tick Aware education program • What must change to improve care for Lyme survivors Eric and Amy also share details about the Pennsylvania Lyme Patient Conference taking place April 18 in King of Prussia, where patients, doctors, and advocates will gather to learn, connect, and support one another. Learn more about the Pennsylvania Lyme Patient Conference: https://palyme.org
Episode 558: Persistent Infection, Molecular Mimicry, and the Future of Chronic Lyme | Amy Proal, PhD
In this powerful and science-forward episode of the Tick Boot Camp Podcast, host Matt Sabatello sits down with Amy Proal, PhD, a leading microbiologist whose work is reshaping how the medical community understands chronic Lyme disease, post-treatment Lyme disease (PTLD), ME/CFS, and Long COVID. Dr. Proal brings a rare combination of deep scientific expertise, lived experience with chronic illness, and real-world clinical integration, offering listeners clarity on why so many patients remain sick long after standard treatment ends — and what science is finally doing about it.
Nikki Schultek – Chronic Infections & The Alzheimer's Pathobiome: The Hidden Pathogens Driving Neurodegeneration
What if Alzheimer's, multiple sclerosis, chronic fatigue, and even psychiatric symptoms are not random but driven by hidden infections? In this episode of Integrative Lyme Solutions, Dr. K sits down with research scientist and Lyme survivor Nikki Schultek to explore the infection hypothesis behind chronic disease. After battling years of misdiagnosed symptoms including asthma flares, interstitial cystitis, arrhythmias, neurological decline, and suspected MS, Nikki uncovered a complex web of infections including Borrelia, Bartonella, Babesia, Chlamydia pneumoniae, Epstein-Barr virus, and more. Now founder of the Alzheimer's Pathobiome Initiative, Nikki is leading a global consortium investigating how stealth pathogens may trigger neurodegeneration, immune dysfunction, and dementia. This conversation dives into intracellular infections, the Herxheimer reaction, amyloid as an antimicrobial response, sterile brain autopsies, precision medicine, and why federal health agencies are finally acknowledging Lyme disease as a serious public health crisis. If you or someone you love is dealing with chronic Lyme, long COVID, autoimmune illness, or cognitive decline, this episode may change how you see disease. Key Takeaways: 0:00 Introduction 3:15 Asthma, air hunger, and early misdiagnoses 8:40 From interstitial cystitis to suspected multiple sclerosis 14:30 Discovering intracellular infections and Chlamydia pneumoniae 18:45 Lyme, Bartonella, Babesia and the whack-a-mole effect 24:10 The Pathobiome concept and microbial imbalance 27:30 Alzheimer's disease and the infection hypothesis 32:00 Sterile brain autopsies and spinal fluid research 35:20 Amyloid plaque as an antimicrobial defense mechanism 41:00 APOE4, genetics, and infection susceptibility 44:30 Federal recognition of Lyme disease and future funding Resources Mentioned: Alzheimer's Pathobiome Initiative - https://alzheimerspathobiome.org ILADS - https://www.ilads.org ILADS Education Foundation - https://www.iladef.org Philadelphia College of Osteopathic Medicine - https://www.pcom.edu Medical Disclaimer: This content is for educational purposes only and is not intended to diagnose, treat, cure, or replace professional medical advice. Always consult your physician or qualified healthcare provider regarding any medical condition or treatment decisions. _______________________________The Karlfeldt Center offers the most cutting-edge and comprehensive Lyme therapies. To schedule a Free 15-Minute Discovery Call with a Lyme Literate Naturopathic Doctor at The Karlfeldt Center, call 208-338-8902 or email info@TheKarlfeldtCenter.comCheck out Dr. K's Ebook: Breaking Free From Lyme: A Comprehensive Guide to Healing and Recovery here: https://store.thekarlfeldtcenter.com/products/breaking-free-from-lymeUse the code LYMEPODCAST for a 100% off discount!
Episode 557: The Stanford Scientist Rewriting the Future of Lyme Disease Treatment — Dr. Jayakumar Rajadas | Tick Boot Camp
In this groundbreaking episode of the Tick Boot Camp Podcast, we interview Dr. Jayakumar Rajadas, a Stanford Medicine researcher who has discovered multiple breakthrough therapeutic candidates for Lyme disease, Babesia, and Bartonella. His work includes the discovery of Disulfiram's effectiveness against Lyme and Babesia, Azlocillin's potent activity against Lyme and Bartonella, and advanced targeted drug-delivery systems designed to preserve the gut microbiome. Dr. Jay's research has been featured in TIME Magazine (Azlocillin) and Forbes (Disulfiram), and connects deeply with the work of leading Lyme researchers, including Dr. Monica Embers (Tulane), Dr. Kim Lewis (Northeastern), Dr. Kenneth Liegner, and Dr. Brian Fallon (Columbia University). This interview delivers hope, science, and unprecedented detail on what may become the next generation of Lyme disease treatments. Key Topics Covered 1. How the Stanford Tick Initiative Sparked a New Era of Drug Discovery In 2012, Stanford launched a major initiative in response to community demand for better Lyme treatments. Dr. Rajadas was selected to lead drug development, focusing specifically on persistent/chronic Lyme disease, where few researchers were working. 2. Understanding Borrelia: Active vs. Stationary Forms & Why Chronic Lyme Persists Dr. J explains the three key survival modes of Borrelia burgdorferi: Active Phase The bacteria are replicating and metabolically active. Easier to kill with standard antibiotics. Stationary Phase Bacteria reach population limits and slow down growth. Represents early persistence mechanisms. Persister Forms Triggered by stressors like antibiotics (e.g., doxycycline). Bacteria fold into round bodies, spiral forms, or compact “cement-like” protective balls. These forms: Shut down metabolic pathways Resist penetration Survive antibiotic exposure Why Doxycycline Can Fail Doxycycline can induce persisters, causing Borrelia to form impenetrable protective shells rather than die. This is why many patients initially feel better, then relapse. 3. Disulfiram (Antabuse): Lyme + Babesia Breakthrough Featured in Forbes One of the biggest scientific shocks of the last decade: Discovery Through Stanford's high-throughput screening of FDA-approved drugs, Disulfiram emerged as a top hit. Clears Borrelia (including persistent forms) Clears Babesia — a major advantage over standard antibiotics Does NOT harm the gut microbiome Is already FDA-approved and widely used for alcohol aversion therapy Highly potent but requires careful dosing due to side effects in inflamed patients. Why Some Patients Improve, and Others Suffer Chronic Lyme patients already have heightened inflammation. Disulfiram is a powerful molecule whose polymorphic forms behave differently in different people. His lab developed: Less toxic formulations Buccal & sublingual delivery systems Rectal delivery options These may reduce neuropsychiatric side effects reported by some patients. Clinical Connections Dr. Kenneth Liegner pioneered clinical use and published cases Dr. Brian Fallon conducted NIH-listed clinical trials. Many clinicians now use Liegner's protocols. Real-world example: Matt shares the story of Brooke Stoddard (Generation Lyme), who regained his life after Disulfiram treatment under Dr. Liegner. 4. Azlocillin: The Antibiotic That TIME Magazine Called a Gamechanger If Disulfiram is the Lyme and Babesia weapon, Azlocillin may be the frontline tool for Lyme and Bartonella. Why Azlocillin Is Revolutionary Eradicates both active and persister forms of Borrelia. Destroys doxycycline-induced “cement ball” persisters by drilling into their vulnerable cell-wall synthesis pathways. Proven effective against Bartonella when paired with azithromycin, based on research by Dr. Monica Embers (Tulane) . The Cell-Wall Vulnerability Breakthrough Persisters STILL must maintain minimal cell-wall synthesis to survive. Azlocillin exploits this tiny vulnerability: It penetrates the protective sphere Breaks the “cement wall” Forces the bacteria out of hibernation Kills them rapidly This discovery is one of the biggest scientific leaps in Lyme research in a decade. The Delivery System That Protects the Gut Microbiome Azlocillin is extremely hydrophilic, making absorption difficult.Dr. Jay fixed this by creating: A magnesium-lipid nanoparticle formulation Designed to release in the upper intestine Avoiding the colon (where most microbiome lives) This allows: High bloodstream absorption Minimal microbiome damage Oral availability of a drug previously only available via IV Why Azlocillin May Be Better Than Disulfiram Hits Borrelia + Bartonella Stronger anti-inflammatory effects No polymorphism issues Fewer side effects Potent against persisters A company is preparing to bring his oral formulation to clinical trials by next year. 5. Loratadine (Claritin): The First Clue from 2012 Before Disulfiram and Azlocillin, Dr. Jay's lab identified Loratadine (Claritin) as a manganese transporter inhibitor of Borrelia. Why it mattered: Borrelia uniquely relies on manganese, not iron. Blocking manganese uptake may weaken the bacteria. The discovery went viral, with many patients reporting improvement even at OTC doses—though the binding affinity was weak. This project introduced the concept of drug repurposing for Lyme to the scientific community. 6. Melittin (Bee Venom) — The Micro-Needle Patch Alternative Bee venom therapy is widely used in the Lyme community, but risks stings and allergic reactions. Dr. J is developing: Melittin micro-needle patches Delivering the active peptide without stinging Using dissolvable, painless needles A safe, controlled, pharmaceutical-grade delivery approach This could modernize bee venom therapy and make it more accessible. 7. Mechanism of Brain Fog & Fatigue in Lyme: A Major Breakthrough Dr. Jay's lab published a neuroscience paper demonstrating: Outer Surface Protein (Osp) Nanoparticles Borrelia sheds lipid-coated outer membrane particles. These form stable nano-vesicles that: Enter the bloodstream Cross into the brain Cause mitochondrial dysfunction Reduce ATP production Result: Brain Fog, Fatigue, Cognitive Dysfunction This explains why neurological Lyme can persist even after bacterial levels drop. This work ties strongly to ongoing research at Columbia University under Dr. Brian Fallon. 8. Collaborations With World Leaders in Lyme Research Dr. J's research intersects with: Dr. Kim Lewis (Northeastern University) Reproduced and validated Disulfiram findings publicly. Helped launch interest in persister-killing therapies. Dr. Monica Embers (Tulane University) Demonstrated Azlocillin + Azithromycin effectiveness against Bartonella. One of the world's foremost experts in persistent infection models. Dr. Kenneth Liegner Early clinical pioneer of Disulfiram therapy. Published stunning recovery cases. Dr. Brian A. Fallon (Columbia University) Leading psychiatrist specializing in post-treatment Lyme. Conducted planned Disulfiram clinical trials. These collaborations form a powerful network accelerating treatment development. 9. New Anti-Inflammatory Discoveries: Galangin & More Dr. Jay recently co-authored a 2025 paper on: Galangin (Thai ginger rhizome extract) Which may reverse cardiac inflammation and fibrosis His team is also exploring other nutraceutical molecules for chronic inflammation relief in Lyme patients. 10. Dr. Jay's Personal Story of Illness and Hope He reveals for the first time: He was diagnosed with Stage 3 Multiple Myeloma Lost the ability to walk Suffered unbearable pain After cutting-edge therapies and research, he is now in full remission His message to Lyme patients: “There is ALWAYS hope.”
Susan Pogorzelski – Lyme Misdiagnosis, Babesia Recovery, Emotional Healing & The Last Letter
What happens when Lyme disease goes undiagnosed for 15 years — and the emotional toll becomes just as devastating as the physical symptoms?In this episode of Integrative Lyme Solutions, Dr. K sits down with Susan Pogorzelski, author of The Last Letter: A Novel and founder of the Lyme Brave Foundation. Susan shares her 30-year journey through misdiagnosis, neurological decline, co-infections like Babesia, severe fatigue, psychiatric symptoms, and the long road of recovery. From being dismissed by doctors to experiencing suicidal ideation during treatment, Susan opens up about the isolation, trauma, and resilience that shaped her healing.This powerful conversation explores Lyme misdiagnosis, Babesia treatment, herxing, emotional trauma, nervous system regulation, EFT tapping, relapse recovery, and how chronic illness can reshape identity. If you or a loved one is navigating chronic Lyme disease, co-infections, or the emotional weight of invisible illness, this episode is both validation and hope.Key Takeaways:0:00 Introduction3:15 15 years of misdiagnosis and declining neurological health8:20 Gallbladder surgery, rapid deterioration, and ER visits12:05 Lyme diagnosis and multiple co-infections confirmed15:40 Babesia treatment and what moved the needle in recovery19:30 Herx reactions, suicidal ideation, and psychological symptoms23:50 Emotional trauma, loneliness, and invisible illness27:45 EFT tapping, nervous system healing, and energetic tools30:10 Relapses, flares, and building resilience over time33:00 Lyme Brave Foundation and supporting patients emotionallyResources Mentioned:Susan Pogorzelski Website - https://www.susanpogorzelski.com/aboutLyme Brave Foundation - https://lymebravefoundation.orgThe Last Letter: A Novel by Susan Pogorzelski - https://www.amazon.com/Last-Letter-Novel-Susan-Pogorzelski/dp/0988875136Medical Disclaimer: This content is for educational purposes only and is not intended to diagnose, treat, cure, or replace professional medical advice. Always consult your physician or qualified healthcare provider regarding any medical condition or treatment decisions.#Babesia #InvisibleIllness #ChronicLyme _______________________________The Karlfeldt Center offers the most cutting-edge and comprehensive Lyme therapies. To schedule a Free 15-Minute Discovery Call with a Lyme Literate Naturopathic Doctor at The Karlfeldt Center, call 208-338-8902 or email info@TheKarlfeldtCenter.comCheck out Dr. K's Ebook: Breaking Free From Lyme: A Comprehensive Guide to Healing and Recovery here: https://store.thekarlfeldtcenter.com/products/breaking-free-from-lymeUse the code LYMEPODCAST for a 100% off discount!
Episode 556: Solving Lyme Diagnostics and Discovering New Tick-Borne Pathogens with Dr. Bobbi S. Pritt
Dr. Bobbi S. Pritt joins Tick Boot Camp Podcast for a scientific deep dive into Lyme disease diagnostics, co-infections, and emerging tick-borne pathogens. Dr. Pritt is Professor and Chair of Laboratory Medicine and Pathology at Mayo Clinic and Director of the Clinical Parasitology Laboratory in Rochester, Minnesota. An internationally recognized expert in vector-borne diseases, she is globally known for discovering new tick-borne pathogens—including Borrelia mayonii and Ehrlichia muris eauclairensis—and for advancing cutting-edge molecular and metagenomic diagnostic testing used nationwide. This episode offers essential clarity for anyone navigating Lyme disease, unexplained symptoms, or confusing test results. Dr. Pritt explains why standard tests often miss early Lyme, how PCR and molecular tools can detect active infection, and what metagenomic sequencing may offer for more accurate and comprehensive diagnostics in the future. Episode Summary Dr. Pritt breaks down how Lyme and other tick-borne diseases are detected through antibody testing, PCR, tissue analysis, and cutting-edge molecular methods. She explains how her lab discovered multiple new pathogens in the upper Midwest, the role of tick species in disease transmission, and why co-infections complicate diagnosis. This conversation also explores geographic spread, climate change, tick behavior, and the strengths and limitations of today's test algorithms. Key Topics • Discovery of Borrelia mayonii as a second cause of Lyme disease in the U.S. • Identification and characterization of Ehrlichia muris eauclairensis • Geographic hotspots and why the upper Midwest produces unique pathogens • Tick species differences: blacklegged vs. lone star ticks and their hunting strategies • Co-feeding in ticks and its role in pathogen evolution • Why early Lyme tests often return false-negative results • The science behind false positives and cross-reactivity • PCR advantages and limitations for detecting Borrelia • When skin biopsies can outperform blood tests • Differentiating Lyme, B. miyamotoi, Anaplasma, Babesia, and Powassan virus • When clinicians should order a full tick-borne disease panel • How climate and ecological changes drive new tick-borne threats • The promise of metagenomics and immune-signature diagnostics What You'll Learn • Why current Lyme testing algorithms struggle in early infection • How new tick-borne pathogens are discovered and validated • Why lone star ticks are more aggressive and changing regional risk • When and why molecular testing is more effective • What symptoms point to co-infections needing additional testing • Why doxycycline is not effective for certain pathogens like Babesia • How metagenomic sequencing could identify every pathogen in a single sample • Where diagnostic innovation is heading and what patients can expect
Dr. Geoff Dow – New Clinical Trial for Chronic Babesiosis: Tafenoquine, Malaria Drugs, and Hope for Lyme-Linked Fatigue
Is chronic babesiosis finally getting the scientific attention it deserves?In this episode of Integrative Lyme Solutions, Dr. K sits down with Dr. Geoff Dow, CEO & President of Sixty Degrees Pharmaceuticals, to discuss a groundbreaking clinical trial targeting chronic babesiosis — a common and often overlooked Lyme co-infection. Originally developed for malaria prevention, the drug Tafenoquine (brand name Kodatef®) is now being studied for its potential to treat persistent Babesia infections and Lyme-related fatigue.They explore the science behind red blood cell parasites, how Babesia differs from malaria, why chronic babesiosis remains controversial, and what makes this new trial the first FDA-reviewed IND study focused on chronic disease. If you or a loved one struggle with Lyme-related fatigue, relapsing babesiosis, or limited treatment options, this conversation offers cautious optimism and a closer look at the future of targeted therapies.Key Takeaways:0:00 Introduction3:10 From Malaria Drug Development to Lyme Co-Infections6:45 How Babesia Infects Red Blood Cells and Causes Fatigue10:40 Why Chronic Babesiosis Is Still Controversial14:50 No FDA-Approved Drugs Specifically for Babesiosis18:30 New Clinical Trials for Chronic and Relapsing Babesiosis24:00 Measuring Fatigue as a Primary Endpoint in Chronic DiseaseResources Mentioned:Sixty Degrees Pharmaceuticals - https://www.sixtydegreespharma.comKodatef® (Tafenoquine) Information - Available via company website aboveMount Sinai (Clinical Trial Site) - https://www.mountsinai.orgYale Babesiosis Case Series (Referenced Study) - https://medicine.yale.eduMedical Disclaimer: This content is for educational purposes only and is not intended to diagnose, treat, cure, or replace professional medical advice. Always consult your physician or qualified healthcare provider regarding any medical condition or treatment decisions. _______________________________The Karlfeldt Center offers the most cutting-edge and comprehensive Lyme therapies. To schedule a Free 15-Minute Discovery Call with a Lyme Literate Naturopathic Doctor at The Karlfeldt Center, call 208-338-8902 or email info@TheKarlfeldtCenter.comCheck out Dr. K's Ebook: Breaking Free From Lyme: A Comprehensive Guide to Healing and Recovery here: https://store.thekarlfeldtcenter.com/products/breaking-free-from-lymeUse the code LYMEPODCAST for a 100% off discount!
Dr. Somer DelSignore – Congenital Lyme, Pediatric Neuroinflammation, and the Hidden Root of Autism
Can Lyme disease begin before birth — and could it be driving neurodevelopmental conditions like autism, ADHD, and anxiety?In this episode of Integrative Lyme Solutions, Dr. K is joined by Dr. Somer DelSignore, a leading pediatric integrative clinician, to explore the overlooked science of congenital Lyme and in utero transmission of vector-borne infections. Dr. DelSignore explains how infections such as Borrelia, Bartonella, and Babesia can cross the placenta, disrupt fetal brain development, and silently fuel inflammation that shows up later as behavioral, cognitive, and immune dysfunction.You'll learn why standard TORCH testing fails to catch these infections, what symptoms parents should watch for in infants and children, and how addressing inflammation, infections, and immune imbalance can dramatically improve outcomes. This episode offers critical insight for parents, practitioners, and anyone focused on true prevention and root-cause healing in pediatric Lyme disease.Key Takeaways:0:00 Introduction and Dr. Somer DelSignore's clinical journey3:10 From pediatric ICU to integrative Lyme care6:20 Congenital Lyme: 40 years of overlooked science9:00 Why TORCH testing misses vector-borne infections12:45 Preconception testing and prevention strategies15:30 Why treating Lyme before pregnancy matters18:05 Infant symptoms parents should never ignore21:10 Autism, neuroinflammation, and misdiagnosis24:15 The RESET framework for pediatric healing28:10 What real recovery can look like for childrenResources Mentioned:IGeneX Laboratories – https://igenex.comTLABDX (Babesia & Bartonella testing) – https://www.tlabdx.com/Horowitz/MSIDS 38 point symptom checklist – https://projectlyme.org/msids-questionnaire/IV Ozone Therapy – https://health.clevelandclinic.org/ozone-therapySOT (Supportive Oligonucleotide Therapy) – https://projectlyme.org/supportive-oligonucleotide-therapy-sot-for-lyme/Medical Disclaimer: This content is for educational purposes only and is not intended to diagnose, treat, cure, or replace professional medical advice. Always consult your physician or qualified healthcare provider regarding any medical condition or treatment decisions. _______________________________The Karlfeldt Center offers the most cutting-edge and comprehensive Lyme therapies. To schedule a Free 15-Minute Discovery Call with a Lyme Literate Naturopathic Doctor at The Karlfeldt Center, call 208-338-8902 or email info@TheKarlfeldtCenter.comCheck out Dr. K's Ebook: Breaking Free From Lyme: A Comprehensive Guide to Healing and Recovery here: https://store.thekarlfeldtcenter.com/products/breaking-free-from-lymeUse the code LYMEPODCAST for a 100% off discount!
Lyme Disease Origins: Dr. Jennifer Miller Explains Why Ticks Are More Dangerous Than You Think
This is episode 76 of the Love, Hope, Lyme podcast. To get your free pdf of "Love, Hope, Lyme: What Family Members, Partners, and Friends Who Love a Chronic Lyme Survivor Need to Know," reach out to Fred Diamond on social media. [NOTE: This podcast does not replace medical treatment. If you struggle with Lyme care, please see a Lyme Literate Medical Doctor.] In this episode of the Love, Hope, Lyme Podcast, Fred Diamond, author of "Love, Hope, Lyme: What Family Members, Partners, and Friends Who Love a Chronic Lyme Survivor" sits down with Dr. Jennifer Miller, who oversees clinical and scientific operations at Galaxy Diagnostics, for one of the most important conversations we've ever had about Lyme disease. We discuss the basics. Not just what Lyme does, but why it happens in the first place. Dr. Miller brings decades of deep scientific experience studying Borrelia burgdorferi and explains: ✅ How ticks actually become infected ✅ Why nymph ("seed") ticks are the biggest threat to humans ✅ What happens biologically inside the tick and inside your body ✅ Why Borrelia is so hard for the immune system (and antibiotics) to find ✅ How co-infections like Bartonella and Babesia complicate diagnosis and recovery ✅ Why some people develop neurological symptoms while others don't ✅ Why today's antibody tests often miss active infections and how Galaxy is working on direct detection methods to change the standard of care We also talk about:
Episode 552: Childhood Lyme Disease, Medical Gaslighting, The Quiet Epidemic, and Becoming the Doctor She Needed – Julia Bruzzese
In this powerful and deeply moving episode of the Tick Boot Camp Podcast, we sit down with Julia Bruzzese, a 22-year-old Lyme disease survivor, disability advocate, and future physician whose life was forever changed by an untreated tick bite in childhood. After developing a classic bull's-eye rash at age 9, Julia went undiagnosed for nearly two years, despite textbook symptoms of Lyme disease. By age 11, she experienced a catastrophic neurological decline that left her paraplegic and wheelchair-bound. Over the next decade, Julia saw more than 100 doctors, endured profound medical gaslighting, and navigated an exhausting journey through antibiotics, IVIG, IV antibiotics, plasmapheresis, stem cells, ozone therapy, and integrative care. Julia's story became internationally known after a moment with Pope Francis on the JFK airport tarmac went viral in 2015—an event that opened doors to care, advocacy, and awareness. She later became the emotional centerpiece of the award-winning documentary The Quiet Epidemic, appeared at New York Fashion Week as a Lyme disease advocate, and was profiled by renowned journalist Mary Beth Pfeiffer. Today, Julia is finishing her undergraduate degree and has been accepted into medical school, determined to become the kind of doctor she needed when the system failed her. This episode is a masterclass in: Pediatric Lyme disease Medical gaslighting vs. lack of education Clinical diagnosis vs. unreliable testing The patient-doctor relationship Chronic illness, disability, and purpose Why Lyme disease changes lives—and why early treatment matters Childhood Lyme Disease & Missed Diagnosis Tick bite and bull's-eye rash dismissed at age 9 Two years of worsening symptoms labeled as “growing pains,” viruses, or psychological Why early Lyme treatment saves lives Neurological Collapse & Hospital Trauma Sudden onset of paralysis, vision loss, fevers, hair loss, and weakness at age 11 Over 100 doctors and repeated hospitalizations Being accused of malingering and conversion disorder The devastating impact of medical disbelief on children The Quiet Epidemic Documentary How Julia became the heart of the film at age 12 Why she initially hesitated to share her story The emotional impact of seeing her illness reflected on screen How the documentary helps families explain Lyme disease to others Meeting Pope Francis & Global Awareness How a school principal secured last-minute tickets The Pope walks directly to Julia's wheelchair The moment that changed everything Media coverage that led to access to lifesaving care Treatment Journey Lyme-literate diagnosis by NP Somer DelSignore Oral and IV antibiotics IVIG (including under-dosing issues) Plasmapheresis POTS, Babesia, Bartonella, and autoimmune complications Stem cell therapy abroad Ozone and integrative protocols Why there is no single silver bullet for Lyme disease The Medical System & Lyme Denial Why doctors often say “it's all in your head” The difference between malice and lack of training How medical education fails chronic illness patients Fear of insurance companies, lawsuits, and “accepted guidelines” Why Lyme is a clinical diagnosis, not a test result Reframing “Medical Gaslighting” Why anger is understandable—but not always healing How patients and doctors can become better partners Understanding doctors' limitations without excusing harm Advocacy with clarity, not hostility Disability, Identity & Resilience Navigating life and education as a wheelchair user Accommodations, accessibility, and invisible illness “I have Lyme. I am not Lyme.” Learning when to rest, when to fight, and when to live Becoming the Doctor She Needed Working as a medical assistant and hospital volunteer in a wheelchair Applying to and being accepted into medical school Becoming the first wheelchair-using medical student at her institution Why lived experience belongs in medicine Medical Malpractice Lawsuit Lawsuit filed in NYC (March 2021) against multiple doctors and hospitals Failure to diagnose and treat Lyme disease despite clear evidence Why Lyme malpractice cases are rare—and necessary Seeking accountability, not revenge Purpose, Faith & Meaning From “Why me?” to “Why not me?” How suffering clarified her calling The role of faith, family, and community Why Julia wouldn't give this journey back—even now Memorable Quotes “I was criminalized as an eleven-year-old child for being sick.” “It actually was in my head—the bacteria was in my brain.” “I have Lyme disease. I am not Lyme disease.” “There is no silver bullet for Lyme. Healing is trial and error.” “I wouldn't be who I am—or know my purpose—without this journey.” Why This Episode Matters This episode is essential listening for: Parents of children with unexplained symptoms Lyme disease and chronic illness patients Medical professionals and students Advocates fighting for better diagnostics and care Anyone who has ever felt dismissed, unseen, or unheard in healthcare Julia Bruzzese's story is not just about Lyme disease—it's about truth, resilience, accountability, and hope.
The Great Mimicker: Is It Lyme Disease or Something Else? | Podcast #469
The Great Mimicker: Is It Lyme Disease or Something Else? | Podcast #469
Episode 551: From Lithuania to Lyme: Dr. Karolina Pras' Journey Through Mold, Long COVID & Chronic Illness — Tick Boot Camp
In this powerful episode, Tick Boot Camp Podcast interviews Dr. Karolina Praskeviciute (“Dr. Pras”), a multilingual, European-trained medical doctor who has lived in Lithuania, Hong Kong, London, and the United States, traveled to 89 countries, and now uses her global experience to understand chronic illness from a unique vantage point. Dr. Pras shares her deeply personal story of lifelong unexplained symptoms, childhood mold exposure, a bull's-eye rash at age 15, and a medical system unequipped to recognize chronic tick-borne illness. After a devastating case of early COVID-19 in February 2020, her immune system collapsed, triggering full-blown Lyme disease, Babesia, Bartonella, tick-borne relapsing fever, MCAS, and Chronic Inflammatory Response Syndrome (CIRS). This conversation bridges both sides of medicine—Western and functional—and explores how chronic illness forced Dr. Pras to reevaluate everything she learned as a third-generation physician. She now brings a rare, dual perspective as both clinician and patient. Key Topics Covered ➤ Growing up in Lithuania: culture, safety, freedom & early mold exposure She describes an independent childhood surrounded by nature—but also living in a poorly insulated home with significant hidden mold that triggered early allergies, stomach pain, nosebleeds, and metallic taste. ➤ Medical school awakening: Why Western medicine failed her symptoms Despite coming from a family of doctors, she noticed early on that conventional medicine couldn't explain many of her symptoms—and she witnessed firsthand how chronic illness is minimized, dismissed, or mislabeled. ➤ The first tick bite at 15 & the bull's-eye rash ignored by doctors Despite developing textbook erythema migrans, pediatricians refused treatment. Her mother initiated a short doxycycline course on her own—far too short to prevent chronic Lyme. ➤ Traveling the world & accumulating exposures After living and working across continents, she now believes different strains, microbes, and environmental factors layered into the perfect storm. ➤ Long COVID as the breaking point Like many chronically ill patients, COVID destabilized everything: massive immune dysregulation nonstop inflammation MCAS flares worsening neurological symptoms Lyme and Babesia fully activating ➤ Mold + Lyme + Long COVID = The Perfect Storm Her CIRS diagnosis revealed why she never recovered even after leaving mold exposure—and why immune dysfunction made Lyme treatment far more complex. ➤ Her diagnostic breakthrough with IGeneX After repeated false-negative Western blots, specialty testing finally uncovered: Lyme Babesia Bartonella Tick-borne relapsing fever (TBRF) Immune activation on FISH testing ➤ Treatment: Herbs, LymeStop, detox, keto, and functional medicine Her current regimen includes: Houttuynia (major reduction in joint pain within 1 week) Cryptolepis (powerful antimicrobial requiring slow titration) Custom herbal protocols (single-herb tinctures) HBOT INUSpheresis Light sauna Gentle lymphatic drainage Vagus nerve support Journaling & limbic system retraining Strict ketogenic diet after a 7-day fast dramatically reduced inflammation She also discusses the risks of Botox, fillers, tattoos, and skincare toxins for chronically ill patients. ➤ Nervous system healing as the foundation of recovery She explains why vagus nerve work and limbic retraining may fail if patients are still in toxin exposure (like mold or endotoxins)—a vital distinction rarely discussed. ➤ Becoming a doctor who understands chronic illness from both sides This episode explores: medical defensiveness gaslighting vs unhealthy doctor-patient dynamics why patients must be empowered, not dismissed why doctors also need compassion and realistic expectations how her future clinical practice will integrate empathy, functional medicine, and lived experience Top Quotes From Dr. Pras “I dismissed my own symptoms because I was trained to believe nothing was wrong unless labs proved it.” “Mold was the silent force that weakened my system long before Lyme took over.” “Healing is not linear. Some days it feels like I'm starting over, but I always come back stronger.” “Doctors have tools—but without a healthy doctor-patient relationship, those tools don't work.” “I can help others now because I know when to push and when to pull back. Lived experience matters.” Where to Find Dr. Karolina Pras Instagram: @drkaromd Email: drkaro@healthkonsultant.com (“consultant” spelled with a K)
Tick-borne diseases continue to expand across North America, but diagnosing them in the clinical laboratory remains complex—especially when timing between symptom onset and testing isn't considered. In this episode of Let's Talk Micro, Luis is joined by Kyle Rodino, Assistant Professor of Pathology and Laboratory Medicine at the University of Pennsylvania and Assistant Director of Microbiology, for a lab-focused discussion on tick-borne disease diagnostics. They cover major bacterial, parasitic, and viral causes of tick-borne disease, and walk through how molecular testing, serology, and microscopy are used at different stages of illness. The conversation highlights why test selection and timing matter, common diagnostic challenges—particularly with Babesia and Lyme disease testing—and how laboratories can support better diagnostic decision-making. A practical episode for microbiologists, laboratorians, and clinicians navigating real-world testing challenges in the lab. Additional resources: Update on North American tick-borne diseases and how to diagnose them https://doi.org/10.1128/jcm.00807-23 Stay connected with Let's Talk Micro: Website: letstalkmicro.com Questions or feedback? Email me at letstalkmicro@outlook.com Interested in being a guest on Let's Talk Micro? Fill out the form here: https://forms.gle/V2fT3asjfyusmqyi8 Support the podcast: Venmo Buy me a Ko-fi
Carter and Payton Bradsky: Building “Ella,” the AI Companion Helping Lyme+ Patients Track Symptoms, Treatments, and Progress
Carter and Payton Bradsky—siblings, co-founders, and the CEO/CTO team behind LymeLess Health—join Dr. Karlfeldt to share a deeply personal and practical conversation about navigating Lyme+ illness and how they're using technology to change the patient experience. With Carter's lived experience battling Lyme disease, Babesia, Bartonella, and mold toxicity—and Payton's background as a former Google software engineer and product manager—this episode connects real-world patient pain points to a new kind of solution: Ella, an AI-powered companion built specifically for Lyme+ patients. Learn more (and find the app) at https://lymeless.com/.You'll hear how their family's journey began with their mother being dismissed after years of symptoms and dozens of doctors—until one chance conversation led to Lyme testing and answers. Carter and Payton break down what it was like to be kids and caregivers, how symptoms can show up differently in each person (from brain fog and anxiety to seizure-like episodes and misdiagnosis), and what actually helped them move toward remission. They also explain why Lyme care is so difficult to manage day-to-day—and how Ella helps patients track symptoms, treatments (including pulsing protocols), and lifestyle factors, then turn that data into actionable insights and shareable reports to improve doctor visits.If you've ever felt overwhelmed trying to remember what changed, what helped, or what triggered a flare—this episode offers a new framework: reduce the burden of “managing Lyme” so you can focus on living again. From weekly insights to provider-ready summaries and a future vision for research breakthroughs driven by patient data (with patient privacy and ownership at the core), this conversation is packed with hope, clarity, and next-step tools.Key Topics CoveredThe Bradsky family's “Lyme was a family affair” origin story—and how diagnosis finally happenedMedical gaslighting and dismissal: “It's all in your head” and the toll it takes on familiesBeing a child/caregiver while a parent becomes bedridden: trauma, coping, and shifting family dynamicsCarter's symptoms (brain fog, anxiety, dissociation) and the impact on athletics and college lifePayton's seizure-like episodes, epilepsy misdiagnosis, loss of license, and eventual Lyme/Babesia/Bartonella diagnosisWhy Lyme recovery is rarely linear: flare patterns, stress effects, and measuring progress when memory is impairedIntegrative treatment approaches: herbals + antibiotics, detox support, probiotics, and pulsing protocolsThe “appointment gap” problem: forgetting symptoms, underreporting, and losing clinical time to catch-upHow Ella works: daily check-ins, trend detection, symptom/treatment tracking, and weekly insightsProvider-facing reporting (“warrior report”) and the long-term goal of precision medicine + research breakthroughs via opt-in anonymized data _______________________________The Karlfeldt Center offers the most cutting-edge and comprehensive Lyme therapies. To schedule a Free 15-Minute Discovery Call with a Lyme Literate Naturopathic Doctor at The Karlfeldt Center, call 208-338-8902 or email info@TheKarlfeldtCenter.comCheck out Dr. K's Ebook: Breaking Free From Lyme: A Comprehensive Guide to Healing and Recovery here: https://store.thekarlfeldtcenter.com/products/breaking-free-from-lymeUse the code LYMEPODCAST for a 100% off discount!
Chronic Fatigue Isn't the Diagnosis: What Most Cases Are Really Hiding
Chronic fatigue and unexplained illness can be incredibly frustrating for patients and practitioners alike. In this episode, Dr. Ritamarie dives deep with Dr. Alison Grimston, a UK-based functional medicine physician, to uncover the hidden contributors to chronic fatigue, including mold toxicity, Lyme disease, Long COVID, and reactivated infections.You'll learn how to approach these complex cases with compassion, advanced testing, and functional strategies including lifestyle, nutraceuticals, and pharmaceutical interventions. This conversation sheds light on why many people continue to struggle despite conventional care and how a root-cause approach can restore hope and health.What's Inside This Episode?Why chronic fatigue syndromes, Long COVID, and post-infectious conditions are often misdiagnosedHow mold toxicity, viral reactivation, and vector-borne infections hide from standard testingFunctional testing strategies for Lyme, Babesia, Bartonella, and other co-infectionsThe role of genetics and nutrigenomics in guiding testing and treatmentIntegrative approaches combining lifestyle, diet, mindfulness, and targeted pharmaceuticalsEarly warning signs practitioners should never overlookWhy patience and multi-layered care are crucial for recoveryResources and Links:Download the full transcript hereDownload our FREE Guide to Supporting a Healthy and Balanced Immune SystemJoin the Next-Level Health Practitioner Facebook group here for free resources and community supportVisit INEMethod.com for advanced practitioner training and tools to elevate your clinical skillsCheck out other podcast episodes hereGuest Resources and Links:Dr. Alison Grimston's website: DrFinlays.co.uk | DoctorAllie.comFree gift
The medical mystery millions are living with: Your tests are normal, so why are you still sick?
America Out Loud PULSE with Dr. Myriah Hinchey – What if your “mystery illness” is not a mystery at all? With more than half a million new Lyme cases diagnosed annually in the U.S.—and research suggesting the true number may be several million—this crisis is far larger than most realize. Lyme disease and co-infections such as Babesia, Bartonella, Ehrlichia, and Anaplasma can impact every...
The medical mystery millions are living with: Your tests are normal, so why are you still sick?
America Out Loud PULSE with Dr. Myriah Hinchey – What if your “mystery illness” is not a mystery at all? With more than half a million new Lyme cases diagnosed annually in the U.S.—and research suggesting the true number may be several million—this crisis is far larger than most realize. Lyme disease and co-infections such as Babesia, Bartonella, Ehrlichia, and Anaplasma can impact every...
Decoding Chronic Illness: Environmental Triggers and Solutions, Part 1
Understanding and Treating Complex Illnesses with Dr. Neil Nathan, author of “Toxic 2nd Edition: Heal Your Body from Mold Toxicity, Lyme Disease, Multiple Chemical Sensitivities, and Chronic Environmental Illness.” Dr. Nathan shares his expertise on the multifaceted nature of chronic illnesses, which often defy simple categorization and may be misdiagnosed as psychiatric issues. The discussion covers the impact of environmental toxins, electromagnetic fields, and infections like Lyme disease and long COVID. Dr. Nathan also highlights the importance of understanding inflammation's complex pathways and offers suggestions for both elimination of root causes and restoration of immune system functionality. The episode provides insights into new diagnostic tools and treatment methodologies for persistent and intrusive health issues.
Episode 252 – Induced Native Phage Therapy (INPT) & advanced natural therapies
David Jernigan 0:15Hello! Dr. Deb 0:16Hi there, sorry for all the confusion. David Jernigan 0:19Oh, no worries, you gotta love it, right? Dr. Deb 0:21Oh, I can’t hear you. David Jernigan 0:23No way, let’s see, my mic must be turned off? Dr. Deb 0:27Hang on, I think it’s me. Let’s see…Okay, let’s try now. David Jernigan 0:40Okay, can you hear me? Dr. Deb 0:42Yep, I can hear you now. David Jernigan 0:43Excellent, excellent. And, how are you today? Dr. Deb 0:48I am good, thank you. How about yourself? David Jernigan 0:50I’m good. Well, it’s good to finally meet you and get this thing rolling. Dr. Deb 0:56Yes, yes, I’m so sorry about that. David Jernigan 0:58That’s alright, that’s alright.So… Dr. Deb 1:01Yeah, go ahead. David Jernigan 1:03So, tell me about yourself before we get going. Dr. Deb 1:06Yeah, so I am a nurse practitioner. I’m also a naturopath. I have a practice here in Wisconsin. I’ve been treating Lyme for about 20 years, so I’m really excited to have this conversation and learn what you’re doing, because it’s so exciting and new. David Jernigan 1:21Well, thank you. Dr. Deb 1:22Yeah, so we treat a lot of chronic illness patients, do some anti-aging regenerative things as well, so… David Jernigan 1:30Yeah, I went to your website and saw you guys are killing it, looks like. Dr. Deb 1:35Yeah. David Jernigan 1:35Got a lot of good staff, it looks like. Dr. Deb 1:37Yeah, we’ve got great staff, great patients, busy practice. We have 5 practitioners, so we have about 15,000 patients in our practice right now. David Jernigan 1:46Well, excellent. Yeah. Excellent. Yeah, yeah.So, I’m excited for this discussion. Dr. Deb 1:53Good, me too. So I pre-recorded our intro, so we can just kind of dive right in, and I’ll just ask you to kind of introduce yourself a little bit, tell us a little bit about yourself, and, and then we can just dive right into it. David Jernigan 2:08All right. I’m Dr. David Jernigan, and I own the Biologic Center for Optimum Health in… Franklin, Tennessee, and I’ve been in practice for over 30 years. I shook Willie Bergdurfer’s hand, if anybody knows who that is. It’s kind of infamous now with some of the revelations that have happened about Lyme being a bioweapon and weaponized. But, you know, I’ve been doing this, probably longer than almost anybody that’s still in the business in the natural realm. It chose me. I did not choose Lyme. Matter of fact, there were many times in my career that I was like. You know, cancer’s easier because of the fact that everybody agrees, you know, what we’re dealing with. And in the 90s, it was a whole different reality, where nobody actually understood that you could have Lyme disease and not be coming from New England.You know, so I had actually the first documented case of a Lyme disease, CDC positive.Patient that had never left the state of Kansas before. So they couldn’t say that it wasn’t in Kansas, and so she had actually been, pregnant with… twin boys, and they were born CDC-positive as well, and so it is transmitted across the placenta we know.So, I, you know, the history of how I did all this was, in the 90s, probably 1996, probably, somewhere in there, 97. With this woman, you know, I… if you go into Robin’s pathology books from back then. Which we all used, medical doctors and everybody else studying. you know, there was basically a paragraph about Lyme disease, and on the national board tests, as you recall, it was probably like, what causes, or what is, bullseye rash associated with? And you’d had to guess Lyme disease, of course. Dr. Deb 4:07Female. David Jernigan 4:08But that was, you know, considered to be more a New England illness, and you would never see it anywhere else. But here was this woman. I knew… nothing about Lyme beyond what we had gotten taught in college, which was, like I say, next to nothing. And she would not let me stop feeding me information. I mean, you gotta remember, the internet wasn’t even hardly in existence in those years. I mean, it was brand new. It was supposed to be this information highway, and So I started purchasing, like a lot of doctors do even now, they start purchasing every kind of new supplement that’s supposed to work for bacteria. There was no product in those days that actually was Lyme-specific. I mean, nobody was really dealing with it naturally. It was always a pharmaceutical situation. Dr. Deb 5:04And a very short course at that. David Jernigan 5:06Yeah, 2 weeks of doxy and you’re cured, whether your symptoms are gone or not, which… she’d had the 2 weeks of doxy, and her symptoms and her son’s symptoms were not gone. And so, I absolutely just purchased everything I could find. Nothing would work. I mean, I could name names of products, and you would recognize them, because they’re still out there today. Dr. Deb 5:28Which is. David Jernigan 5:30Kind of a… A sad thing that natural medicine is still riding on these things that have the most marketing. Dr. Deb 5:37As opposed to sometimes the things that actually have the documented research. David Jernigan 5:42Behind it, and I am a doctor of chiropractic medicine, and I specialized all these years in chronic, incurable illnesses of all types. That may sound odd to a lot of people, but doctors of chiropractic medicine are trained just like a GP typically would be. The medical schools, as I understand it, got together, decades ago and said, wow, if all we did was… Crank out general practitioners for the next 10 years, we wouldn’t have still enough general practitioners to supply the demand. Dr. Deb 6:17Right. Everybody in medicine, in medical schools, wanted to be a specialist, because that’s where the money was, and it was… David Jernigan 6:24Easier, kind of, also, to… you know, just focus on one part of the body, and specialize in that. Dr. Deb 6:31Expert in that one area. David Jernigan 6:32So we all now have the same training. We all go through pre-med. We got a bachelor’s degree, I got my bachelor’s degree in nutrition, and through, Park University in Parkville, Missouri. And so, you know, when I ran out of options to purchase, I just used a technology that I developed, which was an advancement upon other technologies, but I called it bioresonance scanning. And I coined the term back in the 90s. It was a way to kind ofKind of like a sensitive test, you know, like you might. Dr. Deb 7:09I wouldn’t. David Jernigan 7:09Of applied kinesiology, then clinical kinesiology, then chiro plus kinesiology, then, you know, you can just keep going with all the advancements that were made. Well, this was an advancement upon those things, so… I developed… I was the first in… in… my known world of doctors to develop a way to detect adjunctively, obviously we can’t say it’s a primary diagnosis. Adjunctively detect the presence of a given specimen. So we could say, thus saith my test. It’s highly likely you have Borrelia burgdurferi. And, but I had to have the specimen on hand to be able to match what I call frequency matching to the specimen. Brand new concept in those days. And so I was able to detect whether or not my treatments were successful or not. This is something even now that’s really difficult for doctors, because antibody tests, even the most advanced ones, it’s still an antibody test. It’s still an immune response to an infection.And accurately, you know, some doctors will slam those tests, saying, well. That doesn’t mean you actually have the infection, that just means your body has seen it before, which is a correct statement, kind of. So being able to detect the presence, and even where in the body these infections are was a way huge advancement in the 90s, for sure it’s kind of funny, I think about a conference I went to, and cuz… I’m kind of jumping ahead. Because I ended up developing my own formula, just for this woman and her children, and it worked. And I was like, wow! Their symptoms were gone, all the blood tests came back negative. In those days, we were using the iGenX. Western blot, eventually. And the, what was called a Lyme urine antigen test. I don’t know if you remember that, because it… Only decades later did I meet, the owner of iGenX, Nick Harris. Dr. Deb 9:17Person. And I was like, whatever happened to the Luwat test? Because I took it off the market after a while. He said, honestly, we lost the antigen and couldn’t find it again. Oh, no. David Jernigan 9:27And so… but that was a brilliant test. It was the actual gold standard in those days. Again, the world… it can’t be understated how different the world was in the 90s. Dr. Deb 9:40Yeah. David Jernigan 9:41Towards natural medicine, even. Dr. Deb 9:44Oh, yeah. We think… we think it’s bad now, but, like, when I started, too, I started in the early 2000s, like, we were all hiding under the radar, like, you didn’t market, we would have never been on social media, we didn’t run ads, we didn’t do any. David Jernigan 10:00Right. Dr. Deb 10:01Because the medical boards were coming for us. David Jernigan 10:04Came after me. Dr. Deb 10:05Because I had the word Lime on my page, my website. David Jernigan 10:10You know, not saying that I treat Lyme. Dr. Deb 10:13Hmm? David Jernigan 10:13Yes Dr. Deb 10:15Just talking about mind. David Jernigan 10:16And it’s funny, because, once I had this formula, it was something… and I trained in Germany, in anthroposophical medicine, and they’ve been trained in herbal… making herbal extracts, making homeopathic remedies in the anthroposophical methodology, and I trained with the Hahnemann versions of homeopathy, which is just slightly different. Yeah. And, so I was well-versed with making some of my own formulas by that time. And so, it was really something that I wrote on the bottle, you know, and I had to call it something, so I called it Borreligin, which is still in existence, and it’s still a phenomenal herbal remedy right now. And to my knowledge, it’s the only frequency-matched herbal formula. Maybe still out there. Because unless you knew how to do my testing, the bioresonent scanning, there was no way to actually do frequency matching. Matter of fact, as a really famous herbalist attacked me online, saying, oh, none of these herbs will kill anything. And I’m like, that wasn’t what I was saying. I was saying, back in those days, I was saying, well, if… what would the body need to address these infections?You know, not, like, what’s gonna kill the infections for the body. Dr. Deb 11:38Right. David Jernigan 11:39Right? So it was a phenomenal way, but the LUAT test was amazing because what you’d do is you would give your treatment, like an MD would give an antibiotic for a week, ahead of time. Trying to increase the number of dead spirochetes showing up in your urine one day out of 3 days urine catch. So you’d wake up in the morning, you’d collect your urine 3 days in a row, and any one of those being positive is a positive. But it was a brilliant test because it wasn’t an antibody test. They were literally counting the number of dead pieces of Lyme bacteria in your urine. I mean, it was pretty irrefutable. So I had a grand slam on the… the Western blot on patients, and I’d also have a grand slam on the LUAT, and their medical doctors would say, oh, that doctor in the lab are probably in cahoots change some lab. Dr. Deb 12:38Of course. David Jernigan 12:39That come in. And I still see that today. You know, it’s like, oh my gosh, the better the tests are getting. There’s still a bias if you do your own research. Well, if you happen to be a doctor who loves research. And you’re a clinician, so you actually treat patients who’s gonna write the research study? Well, of course, the doctor who did the study, well, he’s biased, and I’m like, I still can’t influence lab tests. Well, lab tests aren’t everything. People scream over the internet at me. It’s like, well, a negative lab test doesn’t mean anything. I was like… I get that with the old Western blot testing. Dr. Deb 13:16Right. David Jernigan 13:16The more sensitive tests, which are very close to 100%, Sensitivity, and 100% specificity. So, meaning, like, they can… if you have the infection, they’re gonna find it. Dr. Deb 13:30They’ll find it, yeah. David Jernigan 13:31And if they… if you have the infection, they’re going to be able to tell you exactly 100% correctly what kind of infection it is. Back in those days, you couldn’t, you could just count the dead pieces, which was… Dr. Deb 13:43Yeah. David Jernigan 13:43Significant, but It’s funny, because when medicine does that, you know, mainstream medicine that’s backed by all the nice foundations who donate millions of dollars towards the research. Their negative tests are significant, but if you fund your own, Yours isn’t that significant. Dr. Deb 14:04Right, or what if we call something a seronegative autoimmune disease, like lupus or rheumatoid arthritis, because none of the tests are positive, but you have all the symptoms. Here, let me give you this $100,000 a year drug. David Jernigan 14:19Yeah. Dr. Deb 14:19And instead of looking for what might actually be causing the symptoms. That’s all okay, but what we do is not okay. David Jernigan 14:27Right. Yeah, it’s a double standard, and it’s getting better. I want to do… tell the world it is getting better. Some of the dinosaurs are retiring. Dr. Deb 14:36No. David Jernigan 14:37Way for people who are… Are more open-minded to new ideas. But, getting back to that woman, she… that formula that I made just for her and her son, I… She went online. Dr. Deb 14:54Which, I had never been on a news group. David Jernigan 14:58Not even sure I knew what one was, you know? Imagine, I’m kind of that dinosaur that… Cell phones were, like, these really big things with a big antenna sticking out of it, and… Dr. Deb 15:09Nope. David Jernigan 15:10So I thought I was pretty hot stuff, just that I actually had a computer software program that was running my front desk. And even then, it was an Apple IIe computer. Dr. Deb 15:21Right. David Jernigan 15:22Probably be pretty valuable right now if I’d kept it, but… Dr. Deb 15:25Mmm… David Jernigan 15:26It being an antique. But, suddenly people were calling my clinic, because the lady with the twin boys that was well was telling people on these research, I mean, these Lyme disease forums and boards online. And, I started going, oh my gosh, you know, as a doctor, it’s one thing to treat a person in your clinic, it’s a different thing to have your clinic name on the label. Like, we all do, Even now, and you’re supposed to write everything that’s on the label, and… all these guidelines, and I’m like, wow, I need to split this off. I mean, I def… I definitely want to help people, and this is… I was pretty excited about the results we were getting. Pre-treat… Pre-treatment and post-treatment. And, so… that’s where I developed, my nutraceutical business in the 90s called Journey Good Nutraceuticals. My advice to anybody thinking about doing the same thing, don’t put your last name on it. Dr. Deb 16:25– David Jernigan 16:25You know, because anytime negative anything comes out, there goes the Jernigan name, you know, the herbal, you know, there’s just all these, and especially nowadays, with all the bots that are just designed to slam natural medicine. Dr. Deb 16:38Yeah. David Jernigan 16:39And that is out there in a… and just ugly people. Dr. Deb 16:42Or should we just say, people with a different opinion? How’s that? David Jernigan 16:46Yeah. That are being less than supportive. Dr. Deb 16:49But. David Jernigan 16:51It was amazing, because by 1999, I presented my research, my first research, I’d never done research. This is what I would… I would say to a lot of people who go, my doctor did… I don’t know, my doctor doesn’t know what you’re doing, my doctor… I was like going, you know, most doctors don’t do research. They don’t publish anything. Their opinion is their opinion, but they don’t back it up in peer review, right? And so that’s what I always tried to do, was back it up in peer review and publish. And so, in 1999, I presented at the International Tick-Borne Diseases Conference in New York City. I’m telling you, it was like the country boy going to the city, you know, I got my… I got my suit on, and I looked all right, and my booth was wonderful, and all these different things, and it was just a big wake-up call.Because what we had demonstrated… let’s get back to the… and this was what I demonstrated with that first study. was that… A positive LUAC test, that Lyme urine antigen test for my Gen X, was a score of 32. Meaning, one of those 3 mornings urine had 32 pieces in the amount of urine they checked of deadline bacteria spirochetes. Okay? Okay. With antibiotic challenges, a highly positive was a score of 45. Dr. Deb 18:19Wow when I would give one dropper 3 times a day for a week. David Jernigan 18:24Ahead of time, and then do the person’s LUAT test, We were getting scores 100, 200… And at that point, we only had a couple, but we had a couple that were greater than 400. Yeah, dead pieces, where the lab just quits counting. They just said, somewhere over 400, right? Dr. Deb 18:45Yeah. David Jernigan 18:46Which, when the medical system at the conference, you know, I was the only natural doctor in the world that was… had any kind of proof of anything naturally that could outperform antibiotics. Can you imagine? Dr. Deb 18:59Yeah. And… David Jernigan 19:01They were just, oh my gosh, incredulous. They’re like, I’ve given the most… one guy came up to me, and to my face, and he goes, I’ve given the most aggressive antibiotic protocols And I’ve only seen one patient over 100. I was like, that makes this pretty significant, doesn’t it? But, it didn’t just, like, make us take off, because guess what? In Lyme world, if a pharmaceutical antibiotic made you feel horrible. That meant it was working. Dr. Deb 19:28That’s right. We used to, back in the day, if you didn’t herx. And had that horrible die-off reaction, for those of you who don’t know what a herx is, but if we didn’t make you herx, we weren’t doing our job right. David Jernigan 19:40You’re looking for your patients to feel horrible, and sometimes to the level of committing suicide. Dr. Deb 19:46Yes. David Jernigan 19:47So bad. Dr. Deb 19:48Yes. David Jernigan 19:49And I was the first doctor, I think, in the world to start screaming and hollering and saying, stop using the worsening of your patient’s symptoms as a guide to good treatment, because they’re… I wasn’t seeing it with my formulas. Because I was doing a comprehensive program of care. I think I was also one of the first doctors to say, we need to detoxify these people as we’re doing this. And you would sit there and say, well, sure you were. I was like, well, remember, there wasn’t a lot of communication. There wasn’t anybody on the internet saying, do this, do that. And, It was, it was interesting in those days. It was, how do you… How do you help the world heal from these things? That they don’t know they have. So later, I actually had a beautiful booth at a health… a big health expo in Texas, I remember, and I was like, you know, you spend a lot of money on the booth, and… Dr. Deb 20:43Yup. David Jernigan 20:43And you’re thinking about it because you’re funding the whole thing, you say, wow, if I only sell one case, I’ll at least cover my cost. Dr. Deb 20:51Yep. Yeah, you’re great. David Jernigan 20:52And I had this beautiful banner of, like, a blown-up tick’s mouth under microscope. You know those beautiful pictures of, like, all the barbs sticking out, and how they anchor themselves in your skin, and… And, thousand people walking by my booth, and they’re just like, keep walking, because they didn’t know they had Lyme. There was, like, and they had MS, maybe, but they don’t have Lyme, and so they just would keep walking. Nobody even knew. Why would I go to a conference in Texas? And I’m trying to say, no, guys, it’s everywhere. Dr. Deb 21:24Yeah. David Jernigan 21:24And… and everybody, you know, yes, you probably have this, you know, kind of thing. If you’re… if you… are chronically ill, almost, of any kind of way. You know, kind of trying to tell people this was… Again, in Robin’s pathology textbooks, one of the few things that it did tell you about Lyme was that it was called the Great… the New Great Imitator. Because it would imitate up to 200 or more different illnesses. So, it’s been an interesting journey, of… educating people, writing articles, but it was interesting, the lady who I first fixed, Laboratory verified, everything like that, symptoms went away, all that kind of fun stuff. Her children were fine, they’ve been fine for years now. When she went on the newsboards in the Lyme disease support groups, It created a war. Oh my goodness, it was like, how dare you? And, say that something natural might actually help, right? Dr. Deb 22:30Right, exactly. David Jernigan 22:32And, I even had… A… one of those first calls to… with a marketing company at one point, way a long time ago. And the lady got on the phone, the owner of the marketing company goes, I would have blood on my hands if I actually took your clinic on. Yeah, you can’t treat Lyme disease, and… Even the big, big associations that are out there are still largely that way. I mean, they’re getting better, but it’s just like… you know, a lot of the times, it’s herbs are good. Herbs will help. Good, you know, but they’re safe. So, it’s still a challenge to… to… present in mainstream Lyme communities, even. Because there’s this… Fear of doing anything outside of antibiotics. Dr. Deb 23:32Yeah, so let me ask you this. From your perspective. Why do you think so many chronic infections exist these days, like Lyme and the co-infections, Babesia, Bartonella, mold illness? And we talked a little bit about herbs and why they, antibiotics and things like that fail, but let’s talk a little bit about that. David Jernigan 23:53So, it’s fascinating. When I trained in Germany, they said that we, as humanity, has moved away from what they called the inflammatory diseases. You know, in the old days, it was. Lots of high fevers, purulent, pus-generating bacterial infections. And I said, as a society, we have… Dr. Deb 24:14Have shifted from those to what they call cold sclerotic diseases, which are your… David Jernigan 24:21Cancers, your diabetes, your atherosclerosis, your… and they said, we’re starting to see what used to only be geriatric diseases in our children. That’s how bad it’s gotten. We have suppressed fevers, we don’t… we don’t respect the wisdom of the human body. So, you know, the doctors say, step aside, body, I will fix this infection for you with this antibiotic. And so, what we’ve done with the, overuse of antibiotics, and this isn’t me just talking from a natural perspective, this is… Right, it’s everybody around the world is acknowledging. I’ll show you… I could show you a, a presentation, if we can do a screen-sharing situation. Yeah. About the antibiotic situation in the world, because it’s really concerning. But what I would say, and kind of like an advancement forward, is we are seeing mutated bacteria. You know, they talked about… do you remember when they found the Iceman, you know, the… You know, the prehistoric guy that’s… In the eyes, and he had Lyme bacteria. I was like, he had spirochetes, maybe. Dr. Deb 25:33Yeah. David Jernigan 25:33That isn’t a modified, mutated version. That’s just maybe the… Lyme… you know, Borrelia… call it Borrelia something, you know, it’s a spirochete, but what we’re dealing with today. Even under strep or staph, as you know, you know, Pseudomonas aeruginosa, you name it, whatever kind of infection a person has is not the same bacteria that your grandparents dealt with. Dr. Deb 26:01That’s right. David Jernigan 26:32It’s a much mutated, stronger, more resistant to treatment type of thing. So, I think that’s one reason. I think the, It’s great that we’re seeing, you know, Secretary Robert F. Kennedy Jr. bringing awareness to things that Like it or not, yeah, seed oils do create inflammation, and everyone in the natural realm, as you know. Has been trying to say this for probably how long? Dr. Deb 26:35Yeah, 25, 30 years. 20 years each. David Jernigan 26:48Yes. You know, thank goodness for people like Sally Fallon and her beautiful book, Nourishing Traditions, that started you know, Dr. Bernard Jensen’s books way back in the day, Dr. Christopher’s books way back in the day. Dr. Deb 26:48Damn. David Jernigan 26:49You know, all of them were way ahead of their time, saying, by the way, your margarine is only missing one ingredient from being axle grease. Dr. Deb 26:58Yeah. David Jernigan 26:58I think that was Dr. Jensen saying that at one point, probably 50, 60 years ago, I don’t know. Dr. Deb 27:03Yep. David Jernigan 27:04So, we’ve created this monster. We, we live in a very controlled environment, you know, of 72, 74 degrees at all times, we don’t sweat, we don’t have to work that hard, typically. You know, most of us aren’t out there like our ancestors were, so that’s making us more and more… Move towards the cold sclerotic diseases, of which even Lyme disease is, you know, which… Yes, it has inflammation, yes, but as a presentation, it’s very often associated with some of these Cold sclerotic diseases of mankind that we see now. Dr. Deb 27:46You have it. David Jernigan 27:47Yeah. Dr. Deb 27:48So, tell me, what is phage therapy? David Jernigan 27:52Well, may I show you a cool video? Dr. Deb 27:55Yeah, I’d love that. David Jernigan 27:56I did not make this video, this is just one of my favorites, because it’s from the National Institute of Health. Let’s see if I can just… Click the share screen thing. And get that to pop up. That’s not what I’m looking for, but it’s gonna be soon. Let’s go here… Alright, can you see that? Dr. Deb 28:18Yeah. David Jernigan 28:19Okay. Modern medicine faces a serious problem. Thanks in part to overuse and misuse of antibiotics, many bacteria are gaining resistance to our most common cures. Researchers are probing possible alternatives to antibiotics, including phages. So, bacteriophages, or we like to call them phages for short, are naturally occurring viruses that infect and kill bacteria. The basic structure consists of a head, a sheath, and tail fibers. The tail fibers are what mediate attachment to the bacterial cell. The DNA stored in the head will then travel down the sheath and be injected inside the cell. Once inside the cell, the phage will hijack the cellular machinery to make many copies of itself. Lastly, the newly assembled phages burst forth from the bacterium, which resets their phage life cycle and kills the bacterium in the process. Someday, healthcare providers may be able to treat MRSA and other stubborn bacterial infections using a mixture of phages, or a phage cocktail process would be first to identify what the pathogen is that’s causing the infection. So the bacterium is isolated and is characterized. And then there’s a need to select a phage in a process known as screening of phage that are either present in a repository or in a so-called phage library. That allows for many of the phages to be evaluated for effectiveness against that isolated I don’t know, bacterium. Phages were first discovered over 100 years ago by a French-Canadian named Felice Derrell. They initially gained popularity in Eastern Europe, however, Western countries largely abandoned phages in favor of antibiotics, which were better understood and easier to produce in large quantities. Now, with bacteria like these gaining resistance to antibiotics, phage research is gaining momentum in the United States once again. NIAID recently partnered with other government agencies to host a phage workshop, where researchers from NIH, FTA, the commercial sector, and academia gathered to discuss recent progress. NIH… So… That is… That is what phage therapy in… is. in what I call conventional phage. Let’s see, how do I get out of the share screen? Hope you already don’t see it. Dr. Deb 30:58Yep, at the top, there should just be a button. David Jernigan 31:00I don’t. Dr. Deb 31:00Stop sharing, yeah. David Jernigan 31:01So… Conventional phage therapy, as you just saw, is a lot like what it is that we’re doing, only the difference is they’re taking wild phages from the environment. They’re finding phages anywhere there’s, like, a lot of bacteria. And then they isolate those phages, and like he said, the gentleman at the very end said we put them in a library, and so there are banks of phages that they can actually now use, and One of the largest banks that I know of has about 700 different bacteriophages, or phages. In their bank that they can pull from. Dr. Deb 31:43Wow. Do you want to take a guess? David Jernigan 31:46How many bacteriophages they’ve identified are in the human gut, on average? Dr. Deb 31:52Oh my god, there’s gotta be more… David Jernigan 31:53Kinds, different kinds of phages, how many? Dr. Deb 31:56There’s gotta be millions. David Jernigan 31:57Well… In population, there’s… humongous numbers, numbers probably well beyond the trillions, okay? Hundreds of trillions, quadrillions, maybe, even. But in the gut, a recent peer-reviewed journal article said that there were 32,242 different types of bacteriophages that live naturally in your intestines, your gut. Dr. Deb 32:25Boom. David Jernigan 32:2632,000. Okay, so… If you read any article on phage therapy that’s in peer review, almost every single one in the very first paragraph, they use the same sentence. They go, Phages are ubiquitous in nature. They’re ubiquitous in nature. So my brain, when I find… when all this finally clicked together, and when we clicked together 5 years into my research, I could not get it to work for 5 years. I just kept going. But that sentence really got me going. I was, like, going, you know. If you look at what ubiquitous means, it says if Phages were the size of grains of sand. Like sand on the beach. They would completely cover the earth and be 50 miles deep. How crazy is that? Dr. Deb 33:24Wow. David Jernigan 33:25That’s how many phages are on the planet. There’s so many… they outnumber every species collectively on the planet. So, it’s an impossibility in my mind. I went, huh, it’s an impossibility that… You catching a, a sterile Bacteria, it’s almost an impossibility. Since the beginning of time, phages have been needing to use a reproductive host. And it’s very specific, so every kind of bacteria has its own kind of phage it uses as a reproductive host. Because phages are… and this is a clarification I want to make for people. just like in the old days, we were talking about the 90s, I talked to a veterinarian that had gotten in trouble with the veterinary board in her state. Dr. Deb 34:14Back in the old days. David Jernigan 34:16Because she gave dogs probiotics. And the board thought she was giving the dogs an infection so that she could treat them and make money off of the subsequent infection. Dr. Deb 34:28Oh my god. David Jernigan 34:29Nobody actually had heard of good, friendly bacteria in the veterinary world, I guess she said she had gotten in trouble, and she had to defend herself, that, no, I’m giving friendly, benevolent, beneficial bacteria. Okay, to these animals, and getting good results.So, phages… Are friendly, benevolent, beneficial viruses. That live in your body, but they only will infect a certain type of bacteria. So… What that means is if you have staff.Aureus, you know, Staphylococcus aureus bacteria. That bacteria has its own kind of phage that infects it called a staph aureus phage. E. coli has an E. coli phage. Each type of E. coli has its own phage, so Borrelia burgdurferi has its own Borrelia burgdurferi type of phage, whereas Borrelia miyamotoi alright? Or any of the other Borrelia species, or the Bartonella species, or the… you just keep going, and Moses has its own type of phage that only will infect that type of bacteria. So that’s… You know, when you realize, wow, why are we going to the environment Was my thought. Dr. Deb 35:54Yeah. David Jernigan 34:55Trying to find wild phages and put them into your body, and hopefully they go and do what you want them to do. What if we could trigger the phages themselves that live in your body to, instead of just farming that bacteria that it uses as a host, because what I mean by farming is the phages will only kill 40% of that population of bacteria a day. Dr. Deb 36:20Wow. David Jernigan 36:20And then they send out a signal to all the other phages saying, stop killing! Dr. Deb 36:24It’s like. David Jernigan 36:2560% of the bacteria population left to be breeding stock. It’s kind of like the farmer, the rancher, who… he doesn’t send his whole herd to the butcher. Dr. Deb 36:35Right. David Jernigan 36:36Just to, you know, he keeps his breeding stock. He sends the rest, right? So, the phages will kill 40% of the population every day, just in their reproduction process. Because once there’s so many, as you saw in the video, once the phage lands on top of the bacteria, injects its genetic material into the bacteria, that bacteria genetic engine starts cranking out up to 5,200 phages per bacteria. Dr. Deb 37:06I don’t know who counted all those… David Jernigan 37:08Inside of a bacteria, but some scientists peer-reviewed it and put it out there. that ruptures, and it literally looks like a grenade goes off inside of the bacteria. I wish I’d remembered to bring that video of a phage killing a bacteria, but it just goes, oof. And it’s just a cloud of dust. So, you’re breaking apart a lot of those different toxins and things. So… That’s… That was the impetus to me creating what I did. That and the fact that I looked it up, and I found out that phages will sometimes go… Crazy. I don’t know how to say it. Wiping out 100% of their host. And it could be a trigger, like change in the body’s pH levels, it could be electromagnetically done, you know, like, there’s been documentation of… I think it was, 50 Hz, electricity. Triggering one kind of phage to go… Crazy and annihilate its host population. There’s other ways, but I was, like, going, none of those fit me, you know? It’s not like I’m gonna shock somebody with a… Jumper cable or something to try to get phages to… to do that kind of thing. But the fact that it could be done, they can be triggered, they can switch and suddenly go crazy against their population. But what happens when they kill 100% of their host? The phages themselves die within 4 days. Dr. Deb 38:45Hmm. Because they can’t keep reproducing. David Jernigan 38:47There’s nothing to reproduce them, yeah. Dr. Deb 38:49Yeah. Especially… unless they’re a polyvalent phage, that means a phage that can segue and use. David Jernigan 38:54One or two other kinds of bacteria. To, as a reproductive host. But a lot of phages, if not the majority, are monovalent, which means they have one host that they like to use. And so… Borrelia, so… my study that I ended up doing, and I published the results in 2021, And it’s a small study, but it’s right in there at the high end, believe it or not, of phage research. Most phage research is less than 30 people. In the study. But, we did 26 people.And after one month of doing the phage induction that I invented, which only… Appears to only, induce or stimulate the types of phages that will do the job in your body. I don’t care what kind of phage it is. I don’t care if it’s a Borrelia phage, it may be a polyvalent phage that normally doesn’t use the Borrelia burgdurferi as its number one. Host, but it can. To go and kill that infection. And the fascinating thing is, there was a brand new test that came out at the same time I came out with the idea, literally the same weekend they presented. Dr. Deb 40:1511. David Jernigan 40:15ILADS conference in Boston in 2019. It was called the Felix Borrelia phage Test. So the Felix Borrelia phage test. Because Borrelia are often intracellular, right, they’re buried down in the tissue, they’re not often in the blood that much. And therefore, doing a blood test isn’t really that accurate. But you remember how there’s, like, potentially as many as 5,200 phages of that type erupt from each bacteria when it breaks apart. It’s way easier to detect those phages, because they’re now circulating, those 52, as you saw in the video. 5,200 different phages are now seeking out another Borrelia that they can infect. And so, while they’re out in circulation, that’s easy to find in the bloodstream. So, 77% of the people, so 20 out of 26, were tested after a 2-week period. After only a 4-day round of treatment. Because according to my testing, remember, I can actually test adjunctively to see if I can find any signatures for those kinds of bacteria. And I couldn’t after 4 days, so we discontinued treatment and waited Beyond the 4 days that would allow the phages themselves to die, so we waited about a week and a half.And redid the test. And 77%, so that 20 out of 26 of the people, were completely negative. Dr. Deb 41:50Wow. David Jernigan 41:52Which, you go, well, it’s just a blood test. Well, no, we actually had people that were getting better, like, they’d never gotten better before. We had one woman who was wheelchair-bound, and in two weeks was able to walk, and even ultimately wanted to work for my clinic. I’m just, like, going… Dr. Deb 42:07I didn’t want to write about all that. I wanted to write about the phages. I was like… David Jernigan 42:12article, I probably should have put some of those stories, because, Critics would say, well, you got rid of the infection, maybe, but… Did you fix the Lyme disease? Well, that’s… there’s two factors here that every doctor needs to understand. There’s the infection in chronic illness, there’s the infection, and then there’s the damage that’s been done. Because sometimes I have these people that would come in and say, well, Dr. Jernigan, it didn’t work for me, I’m still in the wheelchair. And I’m like, no, it worked. Repeat lab test over months says it’s gone, it’s gone, it’s gone. It’s like, we would follow, and 88% of the people we followed long-term were still negative, which is amazing to me. Dr. Deb 42:56And then they have to repair the damage. David Jernigan 42:59It’s the damages why you still have your symptoms. And that’s where the doctor has to get busy, right? Dr. Deb 43:06Right David Jernigan 43:06They were told erroneously by their doctor that originally treated them that they’d be well, they’d get out of the wheelchair, if he could actually kill all these infections. Dr. Deb 43:15It’s not true. David Jernigan 43:16Unless it’s caught early. So I love the analogy, and I’ve said it a thousand times.that Lyme disease and chronic infections are much like having termites in the wood of your house. If you find the termites early, then yeah, killing the infection, life goes back to normal, the storm comes and your house doesn’t fall down. But if it’s 20 years later. Killing the termites is still a grand idea. Right. But you have the damage in the wood that needs to be repaired as well. All the systems… when I talk about damage to the wood, I mean, like. All the bioregulatory aspects of the body, how it regulates itself, all the biochemical pathways, the metabolic pathways we all know about, getting the toxins that have been lodged in there for many years, stopping the inflammatory things that have been running crazy. Dealing with all those cytokines that are just running rampant through the body, creating this whole MCAS situation. Which are largely… Dr. Deb 44:21Coming from your body’s own immune cells called macrophages, which are not even… David Jernigan 44:26It’s not… a virus at all, it’s part of the immune system, it’s like a Pac-Man, and research shows that especially in spirochetes. There is no toxin. Now, I wrote 4 books. I think I wrote the very first book on the natural treatment of people with Lyme disease back in the 90s. Why did I write that? Not because I wanted to be famous, it’s a tiny book, actually, the first one was.I was just trying to help people get out of this idea that you will be well when you kill all the bugs. I was saying, it’s… you need to be doing this. If you can’t come to my clinic, at least do this. Try to find somebody that will do this for you. And that ultimately led to a bigger book.as I kept learning more, and I was like, going, well, okay, now at least do this amount of stuff. And you need to make sure your doctor is handling this, this, this, and this. And so, the third book was, like, 500 and something pages long. And then the fourth book was 500 and something pages long, and now they’re all obsolete with the whole phage thing, because this just rewrites everything. Dr. Deb 45:34Yeah. David Jernigan 45:34It’s pretty fascinating. Dr. Deb 45:37Do you think the war on bugs, mentality created more chronic illness than it solved? David Jernigan 45:44Because of the tools that doctors had to use, yes. We’re a minority, we’re still a minority, you and I. Dr. Deb 45:54Yep. Our doctoring… David Jernigan 45:56Methods I never had, and you’d never… maybe you did, but I’d never had the ability to grab a prescription pad and write out a prescription. I had to figure out, how do I get… and this was… and still my guiding thing, is like, how do I identify, number one, everything that can be found that’s gone wrong in the human body. And what do I need to provide that body? Like, the body is the carpenter. That has to do the repair, has to regenerate, has to do everything, has to get… everything fixed right? We can’t fix anything. If you have a paper cut, there isn’t a doctor on the planet that can make that go away. Dr. Deb 46:38Right. David Jernigan 46:39Of their own power, much less chronic illnesses. So, all the treatments are like the screws, saws, hammers, you know the carpenter must be able to use. So a lot of the time, doctors are just throwing an entire Home Depot on top of the carpenter. In the form of, like, bags of supplements, you know, hundreds of supplements, I’ve seen patients walk in my door with two suitcasefuls. And they were taking 70 bottles, 65 to 70 bottles of supplements, and I’d be just like, wow, your carpenter who’s been working for 24 hours a day, 7 days a week. He’s exhausted. There’s chaos everywhere, you don’t know where to. Dr. Deb 47:22Starting. David Jernigan 47:22He goes, you want me to do what with all this stuff? Dr. Deb 47:25Yep, I’ve seen the same thing. People… thousands, you know, several thousand dollars a month on supplements, and not any better. But they’re afraid to give up their supplements, too, because they don’t want to go backwards, either, and… there’s got to be a better way on both sides, the conventional side and the alternative side, although you and I don’t say it’s alternative, that’s the way medicine should be, but… David Jernigan 47:48Right. Dr. Deb 47:49We have to have a good balance on both sides. David Jernigan 47:52And I will say, too, in defense of doctors using a lot of supplements, I do use a lot of supplements. Dr. Deb 47:57Yeah, I do too. David Jernigan 47:58but I want to synergize what I’m giving the patient so that the carpenter isn’t overwhelmed and can actually get the job done. Like, everything has to work harmoniously together, so it’s not that… It’s not the number of supplements, and why would you need a lot of supplements? Well, because every system in your body is Messed up. My kind of clientele for 30 years. Our clientele, yours and mine. Dr. Deb 48:25Yeah. David Jernigan 48:26They have been sick, For decades, many of them. Dr. Deb 48:31Yeah. David Jernigan 48:31And if they went into a hospital, they honestly need every department. They need endocrinology, they need their kidney doctor, they need their… They’re a cardiologists, they need a neurologist, they need a rheumatologist. I mean, because none of those doctors are gonna deal with everything. They’re just gonna deal with one piece of the puzzle. And if they did get the benefit of all the different departments they need, yeah, they’d go out with a garbage bag full of stuff, too. Dr. Deb 48:57Hey, wood. David Jernigan 48:58Only, they’re not synergized. They don’t work together. You’re creating this chemistry set of who knows how much poison. And I want to tell your listeners, and I mean, you probably say this to your patients as well. There is a law of pharmacy that I learned eons ago, and it applies to natural medicine, too. Dr. Deb 49:21Yep. David Jernigan 49:22But the law says every drug’s primary side effect Is its primary action. So, if you listen to TV, you can see this on commercials. I love… I love listening to these commercials, because I’m like, wow. let’s… let’s… I don’t want to say I’ve named Brandon. I don’t know if that’s…Inappropriate to name a name brand, but let’s just say you have a pharmaceutical that is for sleep. After they show you this beautiful scene of the person restfully sleeping and everything like that, they tell you the truth. It’s like, this may cause sleepiness… I mean, sleeplessness. Dr. Deb 50:04Yeah. David Jernigan 50:04Found insomnia. Dr. Deb 50:06And headaches, and diarrhea. David Jernigan 50:08All the other things, and if it’s an antidepressant, what does the commercial do after it finishes showing you little bunny foo-foo, jumping through a green, happy people? They tell you, this may create depression, severe depression, and suicidal tendencies, which is the ultimate depression. So, I want everyone to understand you need to figure out what your doctor’s tools are that they’re asking you to take, and they’re wanting you to take it forever, generally in mainstream medicine, right? In the hospitals and everything. They don’t say, hey, your heart has this condition, take this medicine for 3 months, after which time you can get off. Dr. Deb 50:48Yep. David Jernigan 50:49not fixing it, right? So… That, on a timeline, there is a point, if it was truly even fixing anything. That you… it’s done what it should do, and you should get off, even if it’s a natural product. It’s just like. Dr. Deb 51:03Right David Jernigan 51:03It’s done what it should do, and you should get off, but instead. you go through the tree… the correction and out the other side, and that’s where it starts manifesting a lot of the same problems that it had. So, anti-inflammatories, painkillers, imagine the number one side effects are pain inflammation. So, the doctor says, well. If you say, hey, I’m having more pain, what does he do? He ups the dosage. And if he… if that doesn’t work, if you’re still in a lot of pain, which he would be, he changes it to a more powerful thing, right? But it starts the cycle all over again. So when you ask me, it’s like, why are we having so much chronic illness? It’s because of the whole philosophy. is the treatment philosophy of mainstream medicine that despises what you and I do. Because we’re… our philosophy from the start is the biggest thing. It’s like… We’re striving for cure. That dirty four-letter word, cure, we’re not even supposed to use it. And yet, if you look it up in Stedman’s Medical Dictionary, it just means a restoration of health. Remission. Everyone’s like, oh, I’m in remission. I’m like, remission is a drug term. It’s a medical term. Again, look it up in a medical dictionary. It is a pharmaceutical term for a temporary pause Or a reduction of your symptom, but because it’s just… symptom suppression, it will come back. It’s… remission is great, I suppose, in… At the end of, like, where you’ve exhausted everything, because I can’t fix everything, I don’t know about you. Dr. Deb 52:41No, I can’t either, yeah. David Jernigan 52:43you know, on my phone consults, I try to always remind people, as much as I get excited about my technologies gosh, I see so much opportunity to fix you. I always try to go, please understand, I’m gonna tell you what most doctors may not tell you on a phone consultation. I can’t fix everything. Dr. Deb 53:03Yeah. David Jernigan 53:03For all of my tricks, I can’t fix everything. Not tricks, but you know, all my technologies, and all my inventions. Phages, too. They are a tool. You know, antibiotics. I think I wrote a blog one time, it should be on my website somewhere, that says, Antibiotics do not… fix… neurological disease, or… I don’t know, something like that. You know, you’re using the wrong tool. I mean, it does what it does. Dr. Deb 53:32Yeah, you’re using a hammer to do what a screwdriver needs to. David Jernigan 53:35Yeah, you know, it’s like it’s… And yet, you can probably tell her… that you’ve had patients, too, that they go, Dr. Jernigan. My throat was so sore, and as soon as I swallowed that antibiotic. I felt better, and I’m, like, going… How long did it take? Oh, it was immediate! I was like, dude, the gel cap didn’t even have time to dissolve, I mean… Dr. Deb 53:58SIBO. David Jernigan 54:00But, it’s not going to repair the tissues that were all raw. kind of stuff. So, I mean, that ulceration of your throat that’s happening, the inflammation, there’s no anti-inflammatory effect of these things. So, I digress a little bit, but phages, too… I wrote an article that’s on the website, that’s setting healthy expectations for phages, because they want… we can see some amazing things happen, things that in my 30 years, I wish I had all my career to do over again, now having this tool. It’s just that much fun. I… when doctors around the country now are starting to use our inducent formulas, there’s, 13 of them now, formulas. For different broad-spectrum illness presentations. I tell them all the same thing, I was like, you are gonna have so much fun. Dr. Deb 54:53That’s exciting. Women. David Jernigan 54:54Winning is fun, you know? I was like. You know, mainstream medicine may never accept this, I don’t know. I feel a real huge burden, though, to do my best to follow a, very scientific methodology. I’ve published as much as I can publish at this time by myself. I never took money from the… the sources that are out there, because what do they do? They always come… money comes with strings. Dr. Deb 55:22Yes, it does. David Jernigan 55:23I don’t trust… I don’t trust… I mean, if you listen to the, roundtable that Our Secretary Robert F. Kennedy Jr. Dr. Deb 55:35Yeah. David Jernigan 55:36On Lyme disease last week the first couple of speakers were, like, pretty legit. I mean, all of them were legit, but I mean, they were, like, senators and congressmen or something like that, I think. And then you have… RFK Jr. himself, who’s legit. Yeah they were fessing up to the fact that, yes, they were suppressing anything to do with Lyme. Dr. Deb 56:00Yeah. David Jernigan 56:00Our… our highest levels of, marbled halls and pillars and… of medicine were doing everything the way I thought they were. They were suppressing me. I was like, how can you ignore the best formulas ever, and still, I think Borreligen, and now, induced native phage therapy are still, I believe, I don’t… I’ve never seen it, I could be wrong. The only natural things that have been documented in a medical methodology. Dr. Deb 56:34Hmm in the natural realm. I mean, all the herbs that we talk about. David Jernigan 56:39You know, there’s one that was really famous for a while, and it said, we gave… so many patients. This product, and other nutritional supplements. And at the end, X number of them were… dramatically better. That’s not research. Dr. Deb 56:57Right. That’s observation. David Jernigan 56:59The trick there was we gave this one thing, and then we gave high-dose proteolytic enzymes, we gave high dose this, we gave high dose that, but at the end of the study, we’re going to point back at the thing we’re trying to sell you as being what did it. Dr. Deb 57:12Which is what we do in all research, pretty much. David Jernigan 57:15Well… Dr. Deb 57:16tried to… David Jernigan 57:17Good guys, I hope. Dr. Deb 57:18Do the way we want, right? In… in conventional… David Jernigan 57:22Yeah. Dr. Deb 57:22Fantastic David Jernigan 57:23Very often, yeah, in conventional medicine, definitely. Yeah. And, it’s kind of scary, isn’t it, how many pharmaceuticals are slamming us with, because they’re… Dr. Deb 57:33Okay. David Jernigan 57:34There’s a new one on TV every day, and there’s. Dr. Deb 57:36Every day, yes. David Jernigan 57:37It’s like, who comes up with these names? They’re just horrible. Dr. Deb 57:40Yeah, you can’t pronounce them. David Jernigan 57:41I want to be a marketing company and come up with some Zimbabwehika, or something that actually they go with, and I’m like, I just made a million bucks coming up with it. I’ll be glad when that’s not on the TV anymore, which… Oh, me too. Me too. Dr. Deb 57:54Dr. Jaredgen, this was really wonderful. What do you want to leave our listeners with? David Jernigan 58:00Well, you know, everyone’s calling for a new treatment. Dr. Deb 58:05Yeah. You bet. David Jernigan 58:08I have done everything I can do to get it out there, scientifically, in peer review, so that if you want to look up my name. Dr. Deb 58:16I published an open access journal so that you didn’t have to buy the articles. Like, PubMed, you have to be a member. If you want to look at a lot of the research, you have to buy the articles. David Jernigan 58:26I’ve done everything open access so that people had access to the information. I honestly created induced native phage therapy to fix my own wife. I mean, I… I was… I used to think I could actually fix almost anything. Gave me enough time. And, I could not fix her. You know, the first 10 years, she was bedridden. Dr. Deb 58:49Wow. David Jernigan 58:50People go, oh, it’s easy for you, Dr. Jernigan, you’re a doctor. Dr. Deb 58:54Oh yeah, right? Yeah. David Jernigan 58:56Oh my gosh, how many tears have been shed, and how much heartache, and how much of this and that. I mean, 90% of our marriage, she was in, bed, just missing Christmas. All the horror stories you hear in the Lime world, that was her, and I could not get her completely well. And, she’s a very discerning woman. I say that in all my podcasts, because it’s. Dr. Deb 59:19Just… David Jernigan 59:16Amazing. It’s like, every husband, I think, should want a wife that’s… Always, right? Not that you surrender your own opinion, but it’s like, it’s… it was literally, I don’t know what, 6 months before the ILADS conference in Boston in 2029… in 2019 that She said, are you going to the ILADS conference this year? And I’m like, I’ve been going for, like, 15, 20 years, however long it’s been going on, and I was like, I’m not gonna go to this one. And, 3 days before the conference, she says, I think you should go. And I go, okay. Like I say, she’s generally right. And that… I bought a Scientific American magazine at the newsstand in the Nashville airport. Started reading a story about phages in that that copped that edition of the Scientific American, and It was a good article, but it wasn’t super meaty, you know. very deep on those, but I just was stimulated. Something about being at elevation. Dr. Deb 1:00:02Yeah. Your own mountains, I don’t know, I get all inspired. David Jernigan 1:00:25And I wrote in the margins and highlighted this and that until it was, like, ultimately, I spent the entire conference hammering this out. And it worked. And it’s been working, it’s just amazing. It’s… We’re over 200 different infections that we’ve… we’ve clinically or laboratory-wise documented. There’s a new test for my GenX called the CEPCR Lyme Panel. like, culture. 64 different types of infections, and I believe right now the latest count is something like 10 for 10 were completely negative. Dr. Deb 1:01:03Wow. David Jernigan 1:01:03These chronically infected people. And so, that hadn’t been published anywhere. So, in my published article, remember I was talking about that 20 out of the 26 were tested as negative for the infection? That doesn’t mean they’re cured, okay? Remember, they’re chronically damaged. That’s how we need to look at it. Dr. Deb 1:01:23funny David Jernigan 1:01:24damaged. You’re not just chronically infected. And, but with 30-day treatment.24 out of the 26 were tested as negative. Dr. Deb Muth 1:01:34That’s amazing. David Jernigan 1:01:35So 92% of the people were negative.Okay? The chances of that happening, when you run it through statistical analysis.The chances… when you compare the results to the sensitivity percentages, you know, the 100% specificity and 92% sensitivity of the…Of the lab testIt’s a 4.5 nonillion to 1 chance that it was a fluke. Isn’t that amazing? Now, nearly… I’m not even sure how many zeros that is, but it’s a lot. Dr. Deb Muth 1:02:08That’s is awesome. David Jernigan 1:02:09Like, if I just said, well, it’s a one in a million chance it was a fluke.Okay.So, lab tests don’t lie. You’re not done, necessarily, just because you got rid of the infections. Now that formula for Lyme has grown to be 90-plusmicrobes targeted in the one formula. So, we figured out we can actually target individually, but collectively, almost like an antibiotic that’s laser-guided to only go after the bad guys that we targeted.So, all the Borrelia types are targeted, all the Babesias, for,the Bartonellas, the anaplasmosis, you name it, mycoplasma types are all targeted in that one formula, because I said.Took my collective 30 years of experience and 15,000 patients.that I would typically see as co-infections and put them into that one formula, so…When we get these tests coming back that are testing for 64, it’s because of that.So, there’s a lot of coolnesses that I could actually keep going and going. Dr. Deb Muth 1:03:15That’s exciting. David Jernigan 1:03:15I love this topic, but I thank you for letting me come on. Dr. Deb Muth 1:03:18Thank you for joining us. How can people find you? David Jernigan 1:03:22Two ways. There’s the Phagen Corp company that is now manufacturing my formulas.That is P-H-A-G-E-N-C-O-R-P dot com. Practitioners can go there, and there’s a practitioner side of the website that’s very beefy with science, and… and all the formulas that were used, what’s inside of all the formulas, meaning what microbes are targeted by each one. Like, there’s a GI formula, there’s a UTI formula, there’s a SIRS formula, there’s a Lyme formula, there’s a central nervous system type infection formula, there’s… And we can keep going, you know, SIBO, SIFO formula, mold formula… I mean, we’ve discovered so many things that I could just keep going for hours, and… Dr. Deb Muth 1:04:05Yeah. David Jernigan 1:04:06About the discoveries, from where it started in its humble beginnings, To now, so… There’s another way, if you wanted to see our clinic website, is Biologics, with an X, so B-I-O-L-O-G-I-X, Center, C-E-N-T-E-R dot com. And, if somebody thinks they want to be a patient and experience this at our clinic, typically we don’t take just Easy stuff. All we see is chronic.Chronic cases from all over the world. Something like 96% of our patients come from other states and countries. And typically, I’ve been close to 90% for my whole career.About 30-something percent come from other countries in that, so… we’ve gotten really good and learned a lot in having to deal with what nobody else knows what to do with. But if you do want to do that, you can contact us. And, if you… If you don’t get the answers from my patient care staff, then I do free consultations. With the people that are thinking about, whether we can help them or not. Dr. Deb Muth 1:05:13Well, that’s excellent. For those of you who are driving or don’t have any way of writing things down, don’t worry about it, we’ve got you. We will have all of his contact information in our show notes, so you will be able to reach out to him. Thank you again for joining me. This has been an amazing conversation. David Jernigan 1:05:30Thank you, I appreciate you having me on. It was a lot of fun. The post Episode 252 – Induced Native Phage Therapy (INPT) & advanced natural therapies first appeared on Let's Talk Wellness Now.
Episode 251 – Chronic Bladder Symptoms, Biofilms, and the Hidden Genetic Drivers
Dr. Deb 0:01Welcome back to another episode of Let’s Talk Wellness Now, and I’m your host, Dr. Deb, and today we’re pulling back the curtain on a topic that barely gets a whisper in conventional medicine. Chronic bladder symptoms, biofilms, and the hidden genetic drivers that keep so many women stuck in a cycle of pain, urgency, and infection that never truly resolves. My guest today is someone who is not only brilliant, but battle-tested, like myself. Dr. Kristen Ryman is a physician, a mom, and the author of Life After Lyme, a book and blueprint that has helped countless people reclaim health after complex chronic illness. After healing herself from advanced Lyme, she has spent her career helping patients recover their most vibrant, resilient selves through her Inner Flow program. Her Healing Grove podcast, her membership community, and her deep dive work on bladder biofilms and stealth pathogens. And what I love about Kristen is that she teaches from lived experience. In 2022, she suffered a stroke. And not only survived it, but rebuilt her brain, resolved lateral strabismus, restored balance, and regained her ability to multitask That journey uncovered her own genetic predisposition to clotting, the very same patterns she sees in her chronic bladder patients. And that personal revelation ultimately led to her Introducing this groundbreaking work that we’re talking about today. So let’s get into it, because bladder biofilms, clotting genetics, stealth pathogens, and real recovery is the conversation women have been needing for decades. And we’ll get started. Where did this one go? There we go. Alright, so welcome back to Let’s Talk Wellness Now. I have Dr. Kristen with me, and I am so excited to talk to her for multiple reasons. A, she’s got a fabulous story, and B, she’s an expert in a topic that nobody’s talking about, and I want to learn from her, too. So, welcome to the show. Kristin Reihman 3:07Thank you! I’m so happy to be here, Dr. Deb. Dr. Deb 3:10Thank you. Well, let’s dive right in, because we have so much to talk about, and you and I could probably talk for hours. So, let’s dive into this conversation, and tell us a little bit about yourself and how you got involved in this. Kristin Reihman 3:23Well, I mean, like so many people, I think, on this path, I had, had to learn it the hard way. You know, I had to find my way into a mystery illness, a complex, mysterious set of symptoms that sort of didn’t fit the… the sort of description of what, you know, normal doctors do, and even though I was a normal doctor for many years, nothing I’d been trained in could help me when I was really debilitated from Lyme disease back in 2011, 20212, 2023. And so I kind of had to crawl my way out of that, using all the resources at my disposal, which, you know, started out with a lot of ILADS stuff, you know, a lot of the International Lyme and Associated Diseases Society, resources online, found some Lyme doctors, and then my journey really quickly evolved to sort of, like, way far afield of normal Western medicine, which is what my training is in you know, I think within a year of my diagnosis, I was, like, you know, at a Klingheart conference, and learning all sort of, you know, the naturopathic approach to Lyme, and really trying to heal my body and terrain, and heal the process that had led me to become so, so ill from, you know. A little bacteria. Dr. Deb 4:29Yeah. Yeah, same here. Like, I’ve been an ILADS practitioner for over 20 years, and when I got sick with Lyme, I was like… how did I not realize this? And I knew I had Lyme before I even was ILADS trained, but when I got really sick and got diagnosed with MS, I never thought about Lyme or mycotoxins or any of that, because I was too busy, head down, doing what I’m doing, helping people. And I, too, had to take that step back, not just physically, but more spiritually and emotionally, and say, how did my body get this sick? Like, what was I doing, and what was I not doing? That allowed this to happen, and now look at this from a healing aspect of not just the physical side, but that spiritual-emotional side as well. Kristin Reihman 5:13Totally. I have the same… I have the same realization as I was coming out of it. I was like, wow, this wasn’t just about, sort of, physically what I was doing and not doing. There was something spiritual here as well for me, and I… I feel like it really was a wake-up call for me to get on the path that I’m supposed to be on, the path that I’m on now, really, which is stepping away from the whole medicine matrix model and moving into, you know, working with really complex people. Listening to their bodies, understanding intuition, understanding energy, understanding all these different pieces that doctors just aren’t trained to look at. Dr. Deb 5:46Right? We don’t have time to learn everything, right? Like, you have time to learn the body and the medical side of things, and that’s a whole prism of itself, but then learning the spiritual energy medicine, that’s a completely different paradigm. That’s a full-time learning aspect, and it’s so different than what we learn in conventional medicine. Kristin Reihman 6:04Yeah, it’s a complete health system. Like, it’s a complete healthcare system. Dr. Deb 6:10Yes, and nobody takes it that seriously, but I, for myself, I’ve been spiritual healing for decades, and it wasn’t until I got really sick that I dived deeper into that and looked at what is it in this world that I’m owning, what belongs to generational things that were brought to me from childbirth and other generations in my family that I’m carrying their old wounds. And how do I clear some of that so that it’s not still following me? And then how do I help my kids so that they don’t have to carry what I brought forth? And it’s just… a lot of people, that may sound crazy, but that’s the kind of stuff that we need to be looking at if we want to truly heal. Kristin Reihman 6:54Yeah, and I think it’s also, it’s inspiring, you know, because when people… and I would tell this to my patients with Lyme and these sort of mystery illnesses, like, look, you are on this path for a reason, and this is going to teach you so much that you didn’t necessarily want to learn, but you need to learn. And this… nothing that you learn or change about your lifestyle or the way in which you move through the world is gonna make you a worse person. Like, it’s only gonna sort of up-level you. You know, it’s gonna up-level your diet, and your sleep habits, and your relationships, and your toxic thinking, like, it’s all gonna change for you to get better, and that’s… that’s a gift, really. Dr. Deb 7:27It really is, and I tell people the same thing. Like, we can look at this as… something that’s happening to us, or we can look at this as something that’s happening for us. And that’s how I looked at my MS diagnosis. This was happening for me, not to me. I wasn’t going to be the victim. And you have a very similar story, so tell us a little bit about your story and what kind of catapulted you into this in 2022. Kristin Reihman 7:52Well, by 2022, I was, like, 10 years out of my Lyme hole, and I had been seeing patients, you know, I had opened my own practice, and I was working for another company, seeing, families who have brain-injured children. I was their medical director, still am, actually. And so I was doing a patchwork of things, all of which really fed my soul. You know, all of which felt like this is, like, me, aligned with my purpose on the planet. And so, based on a lot of my thinking, I sort of figured, okay, well, I’m good now, right? Like, I’m on my path now, like, the universe is not going to send another 2×4. And then the universe sent another 2×4. And in 2022, I had an elective neck surgery. You kind of still see the little scar here for my two-level ACDF. Because I had crazy off-the-hook arm pain for, like, a year and a half that I just finally became, like, almost like it felt like I was developing fasciculations and fiery, fiery pain, and I just got the surgery, and the pain went away. But when I woke up, I was different. I didn’t have a voice. Which is a common side effect, actually, of that surgery that resolves after a few months, and in many cases, and mine did. But I also didn’t have, normal balance anymore, and my right eye turned out a little bit, and I couldn’t multitask. And my job is all about multitasking. As you know, with very complex people in front of you, you’re hearing all these pieces of their story, and you’re kind of categorizing it, and thinking about where they fit, and you’re making a plan for what to work up, and you’re making a plan for what to wait until next time. It’s like all these pieces, right? You’re in the matrix. And I… I couldn’t hold those pieces anymore. And I didn’t realize that until I went back to work a couple months after my, surgery, because my voice came back and was like, okay, well, now I’m going back to work. And then I realized, I can’t do simple math. In fact, I can’t remember what this person just said to me, unless I read my note, and I can’t remember taking that note. What is going on? And so I had a full workup, and indeed, I had some neurological deficits that didn’t show up on an MRI, so they must have been quite tiny. Possibly were even low-flow, you know, episodes during my surgery when my blood pressure drops really low with the medicines that you’re on for surgery. But I, basically had, like, a few mini strokes, and needed to recover from that. So that was sort of the… that was the 2×4 in 2022. Dr. Deb 10:09Wow. So, what are, what are some of the things that you learned during that process of that mini-stroke? Kristin Reihman 10:17Well, the first thing I learned is that, something that I already knew from working with the Family Hope Center, which is that organization I mentioned that helps families heal their kids’ brains, I know that motivation lives in the ponds, and if you have a ding or a hit to the ponds, like, you don’t want to get out of bed in the morning, you don’t want to do the work it takes to heal your brain, in my case. And I remember spending several months in the fall of 2022 just sort of walking around my yard. With my puppies, being like, This is enough. I don’t really need to work anymore, right? Like, I don’t… why do I need my brain back? Like, I don’t need to have my brain back to enjoy life. You know, I’ll have a garden, I have people I love and who love me, like, why do I need to work? Like, my whole, like, passion, purpose-driven mentality and motivation to kind of do and be all the things I always strive to do and be in the world, was, like, gone. It was really interesting, slash very alarming to those who knew me, but being inside the brain that wasn’t really working, it wasn’t alarming to me. I was just sort of like, oh, ho-hum, this is my new me.Well, luckily I have some people around me, I like to call them my healing team, who sort of held up a mirror, and they’re like, this is not you, and we’re gonna take you to a functional neurologist now. And so, I ended up seeing a functional neurologist who, you know, within… within, like probably 6 visits. I had all these, like, stacked visits with him. Within 6 visits, my brain just turned on. I was like, oh! Right! I need my brain back! I gotta fix this eyesight, I gotta get my balance back, and I gotta learn how to do simple math again and multitask. So, after that sort of jumpstart, I actually did the program that I, you know, know very well inside and out from the Family Hope Center, where I’d been medical director for 10 years. And, it’s a hard program, it’s not… not for wimps, and it’s certainly… I wasn’t about to do it when I had no motivation, so I’m really grateful to the functional neurologist who helped me kind of, like get my brain… get my pawns back, and my motivation back, my mojo. And then I’m really grateful to the Family Hope Center, because if I didn’t have that set of tools in my back pocket, I would still have an eye that turns out to the side, I would still have a positive Romberg, you know, closing my eyes, falling over backwards, and I would still have, a lot of trouble seeing patients, and probably wouldn’t be working anymore. Dr. Deb 12:32I can totally relate to that. When I got my MS diagnosis, you know, there’s a period of time where you go, okay reality kicks in, and I’m thinking, okay, how long am I going to be able to work? How long am I going to be able to play with my kids and my grandkids and be able to be me? And I started looking at, how do I sell my practice, just in case I need to do this? How do I step back? And I spent probably about 9 or 10 months in that place of, this is gonna be my life, and it’s not gonna be what I’m used to, and, you know, how are we gonna redesign my house, and do this, and that, and… Finally, my husband looked at me one day, and he’s like, what the hell is wrong with you? And I was like, what are you talking about? He’s like, this is ridiculous. He’s like, you fix everybody else. He’s like you can fix yourself. Why do you think you can’t fix yourself, or you don’t know the people that can fix you? You need to get out of this, and pick yourself up, and start doing what you tell your patients. And… and I sat there, and at first I was like just did he know that I’m sick? Like, I have MS. I took that victim mode for a little bit, and then I went, no, he’s right. Like, this is my wake-up call to say, I can reverse this, I can fix this, and total, total turnaround, too. Like, I started reaching out to my friends and colleagues, because I kept myself in this huge bubble, like, I didn’t want anyone to know what was going on with me, because I was afraid my patients wouldn’t see me, what are my staff going to say? My staff are going to leave, and if I lose my business, what am I going to do? And da-da-da-da, all those fears. And then… when I finally started opening up and sharing with people, people started bringing me other people, and you need to talk to this person, you need to talk to this person. They connected me here and there, and this place, and 18 months later, I was totally back to normal again. And now my practice is growing, and we’re adding on, and it’s bigger, and I’m taking on more projects than I feel like myself, and… and I was a lot like you, too. Like, I couldn’t remember my protocols that I’ve done for 20 years. I had to depend on what was in the EHR to pull forward, because I always had them in my notes, so I didn’t have to type them all the time, but I was like I have to pull that forward, because I don’t remember the name of the supplement that I’ve used for 15 years. I don’t remember what laps I’m ordering. I don’t remember the normal values of this stuff. And now it’s back on the tip of my tongue, but at the time, it was a little scary, for sure. Kristin Reihman 14:47Wow, so scary. Well, that’s a remarkable story, and why I can’t wait to have you on my podcast, but I’m really… I’m really happy that you had a healing team around you, too, who was like, yeah, nope, that’s not your… that’s not the train we’re on. Get off that train. Come back on your usual train. What are you doing over there? Dr. Deb 15:03Yeah, and you know, I hope that a lot of patients have that, or people that are experiencing this have that, but there’s so many people who don’t have that. And they need somebody, they need somebody in their corner, like we had in our corners, to help pick them up and say, this doesn’t have to be your reality. It can change, but it is a lot of work, like you said. It’s a lot of work. It’s not… Kristin Reihman 15:25Yeah, no, it’s a lot of work. So when I started off. I was work… I was doing probably 4 hours a morning, like, 4… basically, my entire morning was devoted to brain training and healing my brain through the ref… you know, we… I mean, I can get into the details of it, but basically it’s a lot of, like, crawling on the floor. On your belly, creeping on your hands and knees, doing reflex bags to stimulate, you know, more blood flow to the brain, doing a lot of smells. You know, and just staying with it, you know? And I remember balking, even in the beginning, I was, like, seeing some changes, I was feeling more motivated. I remember feeling this… I started noticing it was changing about 2 weeks in, when I would get up in the morning. And I would… I noticed I would start… I would do my, like, beginnings of the day, I would get the kids on the bus, I would do everyone’s breakfast, I’d do the dishes, and I’d be, like, sitting down and being like, hmm, like, what am I supposed to be doing now? Like, where… What is my purpose today? And because I had this plan, I was just like, well, I know that has to happen, so I may as well do that now. And I would get on the floor, and I would start crawling down the length of our hallway. And within about 8 laps, I would feel my brain, like. I felt like it integrating. I would feel things, like, just coming online, and I’d be like, oh, right. I know who I am, I know what I’m doing today, I have these other things this afternoon, I gotta get this done before noon, and I would do it. But it was really interesting, and I’ve never been a coffee drinker, but when I thought of what that felt like, to me, that’s how people often describe, like, my brain doesn’t wake up until I have coffee. I never needed coffee to have… my brain woke up before I’d wake up, and I’d be like, bing, and I’m ready to go. But when I had the brain injury for those 9 months, it wasn’t that way the whole time. In the beginning, it was very hard to get my brain back in the morning, and it was creeping and crawling that would pull it in. Dr. Deb 17:08Wow. Is there one particular thing that you did that you felt made the biggest difference to rebuilding your brain? Kristin Reihman 17:15Crawling on my belly like a commando, wearing elbow pads, knee pads, actually two sets of knee pads, wearing toe shoes, and just ripping laps on my floor. Dr. Deb 17:26Oh, and that’s so simple to do. So why does that work? Kristin Reihman 17:31So interesting, and I… this is the kind of… this is the… the story of this is something that I think is bigger than all of us, and I wish everybody knew how to optimize your brain using just the simple hallway in your house. But essentially, if you take a newborn baby. And you put them on mom’s belly, and they’re neurologically intact, and maybe you’ve seen videos of this. There used to be a video circulating about a baby born onto mom’s belly, nobody touches the baby, and in about 2 minutes and 34 seconds, that baby crawls on its belly, like, uses arms, uses its toe dig with its little babinsky, and pushes its way up to mom’s breast. Latches on with its reflexes, and there you go. That baby keeps itself alive through its primitive reflexes. So it’s essentially telling its brain, every time it runs those reflexes, every time it does a little toe dig, every time it, like, swings its arm across in a cross-later, hetero… what do we call, a homolateral pattern. That little baby is getting a message to its brain that says, grow and heal and organize. And because all the reflexes come out of the middle and lower brain stem. That’s the part of the brain that’s organizing as a baby. And as a baby grows and does the various things a baby does using its reflexes, like eventually on its belly, crawling across the floor, and then popping up to hands and knees, and creeping across the floor, and eventually standing and walking, all of those things are invoking a different set of reflexes that tell the brain to grow and heal and organize. So it’s almost like the function creates the structure, and if you run those pathways again and again and again your brain will get the message to basically invoke its own neuroplasticity, and that’s how a baby’s brain grows. And it turns out, any brain of any age, if you put it through those same pathways, it will send a message of neuroplasticity to the brain, and the brain will grow and heal and organize. Dr. Deb 19:16That was going to be my question, is why aren’t we using this for elderly people with dementia, or Alzheimer’s, or stroke, or Parkinson’s, or things like that, to help them regrow their brain? Kristin Reihman 19:28Well, because number one, nobody knows about it. Number two, even when people do know about it, nobody likes to be on the floor like a baby, creepy and crawling. And least of all the stubborn old people with dementia who are, like, who don’t even think they have a problem. I mean, the problem with the brain not working, as I discovered, and it sounds like you discovered, too, is the brain that’s not working doesn’t know it’s not working, or worse, doesn’t care. You know, and so it’s tricky with adults. With kids who, you know, you have some sort of power over, you can often make your kids do things that they don’t want to do, like eat their vegetables, or creep and crawl on the floor for 80, you know, 80 laps before they get to go, you know, do their thing. But adults are a little trickier. Dr. Deb 20:10Is there another way for us to be able to do that same thing without the crawling on the floor? Like, could they do it in a sitting motion, or do they need that whole connection to happen? Kristin Reihman 20:21Well, they need to be moving in a cross pattern, and they need to be moving their arms and their legs in such a way that stimulates the reflexes. But you can do that on your bed, you can do it face down on your bed by getting into a pattern, and switching sides and, you know, moving your legs and your arms in the opposite… in the, you know, an opposite cross pattern, and that will get you some of the benefit. And we, in fact, we have… we work with kids who are paralyzed and who don’t… aren’t able to independently move forward in a crawling pattern, who have people coordinating their movements so that they get the same movement, and the brain registers it, and they do make progress, and some of them eventually. Crawl, and then creep, and then walk. Dr. Deb 20:59Wow, that’s so… and it’s so simple and easy for people to do. Kristin Reihman 21:04Well, it’s simple. I don’t know that it’s easy. I do… I do… having done it myself, I will say it’s probably the hardest thing I’ve ever done, was literally crawl my way out of that brain injury. And I’m so glad that I knew what to do, and I’m so glad I had people push me to remind me that it was important, because… I’ll even… I’ll share another story of my own resistance. So, about 2 or 3 weeks into it, I was up to 300 meters of crawling on my belly. And 600 meters of creeping on hands and knees, which was really killing my knees, which was why I was wearing two knee pads. And, I started to get this feeling that maybe I wasn’t doing enough. Like, even though I was noticing changes, and even though I was feeling more purpose, and I was getting organized in the morning, I could tell it was making a difference. I… I knew, I remembered that usually the kids on our program are doing a lot more than that, including my own… my youngest kids, but I made them creep and crawl, even though they didn’t have serious brain injuries, I just thought, we’re gonna optimize everyone, get on the floor, get on the floor. Lord so I was… I was nervous about not doing enough, so I… I reached out to the member… one of the members of the team, and I said, you know, hey, Maria, what’s… what do you think about my numbers? And here’s a… here’s a video of me creeping and crawling, what do you think? Am I doing it right? And she said, you’re doing it right, but how many, how many meters are you doing? And I said, I’m doing 300 meters of crawling on my belly, and 600 meters of creeping, and she’s like, oh. Yeah, that’s not nearly enough for an adult. She’s like, Matthew probably gave you those numbers because he felt bad for you and thought you were going to be still working. He didn’t know you were going to take off from patients. Now that you’re… since you’re not working, you need to do more. I was like, okay, tell me… tell me how much I’m supposed to do. And she goes, you need 900 meters of crawling on your belly, and 3,600 meters, 3.6 kilometers of basically crawling on my hands and knees. Dr. Deb 22:51Oh my gosh. Kristin Reihman 22:52And I just shut down. Dr. Deb 22:54Yeah. Kristin Reihman 22:55I was like, okay, screw it. I’m not doing it. Dr. Deb 22:58And I spent a day or two just not doing it and feeling petulant, and then I was like, you know what? Kristin Reihman 23:01Forget that, I was noticing some benefit. I’m gonna do my 300-600. So, the next day, I went and did 300 and 600 while my daughter was at physical therapy, and we got back in the car, and I said, hey, I’m so excited, I finished my… all my creepy and crawling, and it’s only 10 a.m. on a Saturday, I’m done for the weekend. And she did this. She’s sitting in the car, she looks at me, she goes. Was that your whole program, or was that a third of your program? Dr. Deb 23:28How old is she? Kristin Reihman 23:01Well, she’s, like, 20 now, but she was 18 at the time, and she… she had my number, and I was like, Tula! How can you say that? I’m working so hard! And she’s like, Mom? You need to stop seeing patients completely, and do what they tell you at the Family Hope Center. Because we’re your family, and this is your brain we’re talking about, and we need you to have all your brain back. And I must have looked terrible, because she goes, too much? Dr. Deb 23:54You raised a good daughter. Kristin Reihman 23:58And I was like, well, let me tell… let me ask you, do you mean that? She goes, yeah, I really mean that. I’m like, then it’s not too much. I needed to hear that. Thank you. And I went home, and I finished another 600 of crawls. I didn’t… I never got up to 3,600 of creeps. It was just too much for my knees. I got to 900 and 900, but that was the end of my resistance, and I just did it. Dr. Deb 24:17I just did it. Yeah, your family needed you, right? I mean, when somebody in your family that you love tells you they need you, that’s a huge motivating factor. Kristin Reihman 24:27Yeah, yeah, I’m so grateful for that. So, I did that for 9 months, and at the end of 9 months, my eye was straight and stayed straight, my balance was back, I was multitasking again, and I could take, you know, days and days off of creeping and crawling and not notice a dip. I was like, I’m done. Dr. Deb 24:45Wow, that’s awesome. Kristin Reihman 24:46Yeah. Dr. Deb 24:47During this process, you also discovered that you’re part of 20% of the people with clotting genetics. Tell us a little bit about that. What’s your understanding in that? Kristin Reihman 24:58Well, so, I’ll back up. So, before I had my stroke, I had already been seeing patients with really complex, you know, patients like yours, really complex stories, lots of different things going on, kind of the perfect storm for if they got a tick bite, they tanked. Dr. Deb 25:12and… Kristin Reihman 25:13And I’m one of those people, and my patients were those people. And about 7 years ago, I had one of these patients who said to me, you know, I’ve never told you this, but when I was in my 20s, I had so many bladder infections, so much, like, you know, kind of interstitial cystitis, they said it was, and they said it wasn’t an infection, but it felt like one. And I’ve been doing a little research, and I’ve learned about this woman whose name’s Ruth Kriz, she’s a nurse practitioner, and she sees Patients, and she has… she works with practitioners, and she basically heals interstitial cystitis. And I want you to work with her, I want you to learn from her. And I was like, I’m game. That sounds really interesting, I have no idea what she’s doing, and you don’t usually hear the words cure and interstitial cystitis in the same sentence, so, like, I’m in. So I reached out to Ruth, and long story short, I’ve been working with her for the last 5 or 7 years basically increasing the number of patients who I’m diagnosing now with these hidden bladder infections that are really often what’s at the root of these interstitial cystitis symptoms, meaning, you know, you go to the doctor, you pee in a cup, they look for something, they say there’s no infection here, so, you know, you’re probably crazy, or, you know, you probably have just a pain syndrome, we can’t help you. And actually, if you look with a much more sensitive test, and if you break down the biofilms where these bugs kind of are living in the bladder, you find them. And then you can treat them, and then people get well. So I knew about this, and I, didn’t have any bladder infections that I knew about, and what I did start to think about after my stroke was, well, maybe, since these people who have these bladder infections often have issues breaking down biofilms, the same genetics that lead you to have trouble breaking down biofilms, which are these places where the bugs are kind of hiding in your body, have trouble breaking down clots. And I just had some strokes. I wonder if I have maybe some of these clotting genetics that I’m looking for in all my bladder people. And so I looked, and surprise, surprise, I had not one, not two, but, like, six of them. Ruth said to me, Ruth said, Darlin, I don’t know how you’re standing up. This is more than I’ve ever seen in any of my patients. And she’s been doing this for, like, 4 years now. I was like, oh boy, that’s not good. But in retrospect, it made a lot of sense to me, because having the clotting genetics I have. puts me at risk for severe, you know, chronic Lyme that’s intractable, which I had. It puts me at risk for trouble with, you know, having surgery and clotting and, you know, low blood pressure and low flow states. It puts me at risk for the cold hands and cold feet that I had my entire life until I started treating the clotting issues by taking an enzyme that breaks down little microclots. I mean, I was the person in med school who’d put my hands on people, be like, I’m so sorry. My hands are ice. Warm heart, cold hands, warm heart. Yeah, not anymore, because I’ve treated it. But yeah, so I was surprised slash not surprised to find that I’m one of the people in my community who is a setup for chronic infections and, strokes and bladder infections. Dr. Deb 28:22So you just had that predisposition that took you down that path. Kristin Reihman 28:28Yeah, I think so. Dr. Deb 28:30What are some of the layers of biofilm and the stealth pathogens, like tick-borne diseases and things like that, hiding inside us that… what are some of the symptoms look like, and how do they look different in people with clotting disorders versus the common tick-borne disease? Kristin Reihman 28:47I would say they’re very similar, so it tends to be poor peripheral circulation, so if you put your hands on your neck, and your hands feel cold to your neck difference in the heat, right? The amount of blood flow in your sort of axial skeleton and area as compared to the periphery. And that can indicate a biofilm kind of predisposition or a clotting disposition. It doesn’t necessarily mean it’s there, but it’s a clue, right? Another clue is a family history of any kind of clotting disorders. So, miscarriages, heart attacks, especially early heart attacks, strokes, especially strokes in young people. These things are… are clues that we should probably look for some kind of clotting issue. And of course, in my population, I’m always thinking about it now, because if you have not been able to get well with the usual things for Lyme disease, for example, or Babesia or Bartonella, all of which, by the way, can form biofilms or, you know, love to live and hide in biofilms, then chances are your body’s having a hard time addressing those biofilms. And it turns out, so the connection between the clotting and the biofilm piece is that the same proteins that our body uses to break down Biofilms are used to break down microclots, blood clots, and soluble fibrin, which are the sort of precursors to those clots. And so, if we have an issue kind of grinding up those just normal flotsam and jetsam in our blood flow, then our blood flow is going to become sticky, and our blood will become sort of stagnant and sludgy, and that’s sort of a setup for not being able to heal from infections. Dr. Deb 30:25Is one of the genetic markers you look at MTHFR? Kristin Reihman 30:28I look at that, but I don’t consider that a clotting issue, unless it leads to high homocysteine. So, homocysteine can be either high or low, they’re both problematic. And MTHFR can create either an over-methylation situation, and sometimes if people have low homocysteine, it’s almost worse, because they’re such poor detoxers that they can’t actually get anything out of their system, and they get sludgy for that reason. But I think in terms of the clotting, the bigger issue is high homocysteine, which, you know, typically the MTHFRs, the 1298 would be more implicated for that. Dr. Deb 31:02Yeah, it kind of sets you up. Dr. Deb 31:04Yeah, yeah. Kristin Reihman 31:05I’m curious what you’re seeing. I know since the pandemic, we see a lot of people with elevated D-dimer levels.Are you seeing some of that in your practice, too? Like, we’re seeing more of it, and now that you’re talking about this, I’m wondering if some of those people are predisposed to some of these genetic makeups, and that’s why we’re seeing such a high rise in that.It… and this is connected, and it’s a piece we’re missing. Kristin Reihman31:29Yes, I do think it’s a piece we’re missing. There was a very interesting study that came out of South Africa. A physician in his office did a clinical study on his patients using 3 blood thinners. So he put people on Plavix, and Eliquis, and aspirin, all at once. It… yeah, you’d be hard-pressed to find a doctor in the States to, like, you know, kind of risk that, because most people don’t even want people on aspirin and Flavix at the same time. Dr. Deb 31:55But Kristin Reihman 31:56They put them on 3 different blood thinners, people with long COVID, and in 6 months, 80% of those people were completely free of symptoms. Dr. Deb 32:04Wow. Kristin Reihman 32:05Yeah, yeah. Now, my question is, what about that 20%? Like, what’s going on with them? And I suspect, they weren’t looking at the other half of the pathway, because when you give a blood thinner, you’re not doing anything to help the body break down clot. You’re simply stopping the body from making more of it. And you rely on the body’s own mechanisms, you know, plasminogen activating inhibitor, for example to kind of grind up those clots and take them out. But when people have a mutation, say, in that protein, they’re not going to be able to grind up the clots, and so my suspicion is the 20% of people who didn’t get well in that study were people who had issues on the other side of the pathway. Dr. Deb 32:44Yeah, they weren’t able to excrete that out and maybe have some fiber and issues and things like that, and that wasn’t being addressed. Kristin Reihman 32:50Yeah Dr. Deb 32:51Yeah Kristin Reihman 32:52Of course, COVID makes its own biofilm. There’s a whole… there’s a whole new, you know, arm of research looking at sort of the different proteins that get folded in the body when COVID spike proteins are in there, kind of creating these almost, like, little amyloid plaque situations in your blood vessels. So, I do think that people who can’t break those down are really at risk for both COVID and the shots. You know, the spike protein comes at you for both of those, right? Dr. Deb 33:17Yeah. Did you use any lumbrokinase or natokinase in your situation? Kristin Reihman 33:22So lumbar kinase is what I use. It’s my main player. I use the Canada RNA one, which is, you know, I think, you know, more studied than any of the other ones, and because of its formulation, it’s about 12 times more potent than anything else out there. So that’s what I’m pretty much on for life. You know, that’s… I consider that kind of my…My… my main game. Dr. Deb 33:44Yeah, I agree, I love Limerocheinase for that, that’s really good. So you recently hosted a retreat around this topic. What were some of your biggest aha moments for the participants as they started unraveling some of these biofilm layers? Kristin Reihman 34:00Yeah, no, it was so fun. My sister and I host retreats together. She came out from California and did the yoga, and I did the teaching about biofilms and bladder issues, and it was really fabulous, because a lot of these folks are people already in my community. A few of them were new, and so we had this wonderful Kind of connection, and learning together, and just validation of what it is to live with symptoms that are super inconvenient, you know? Like, one of the… one of the members even, or participants even brought a big bag of, like, pads, and she’s like, listen, ladies. This is what I’m going to use to get through the week. If you want to borrow, I’ll put my little stash over there, and I think they all went by the end of the week. So we… my aha moment was just how powerful it is to be, hosting community and facilitating conversations where people really feel seen and heard, and just how important that is, especially post-COVID, right? When we, you know, so many people just really missed that piece of other humans. And, yeah, I love… I love being able to help people connect around stuff like that. Dr. Deb 35:00That’s awesome. So, for people who are listening that have that mystery, quote-unquote bladder issue, frequent UTIs, interstitial cystitis symptoms, or pelvic pain, or bladder spasms. Where should they start, and what are the first clues that tell you this is biofilm-driven? Kristin Reihman 35:20So, I think it’s always a good idea to… to do a test, you know, to take a microgen test. There’s a couple companies out there, I think Microgen’s the one that I rely on more than any of the others, and it requires, you know, not only doing a very sensitive test like Microgen, but breaking down biofilm before you take it. So, I always encourage people to take a biofilm breaker like lumbrokinase for 5 days leading up to the test, so you’re really grinding into the bladder wall and opening up those biofilms so that when you catch whatever comes out of your bladder, there’s something in there. If you don’t have bladder biofilm, nothing will come out, and you’ll have a negative test, and that’s usually confirmatory. If you’ve done a good provoking with BLUC or, you know, lumbrokinase for 5 days, and nothing comes out then I usually say mischief managed. That’s… that’s a great… that’s great news for you, right? And most people in my community, when they look, they find something, because, you know, not for nothing, but you’re in my community for a reason, right? Dr. Deb 36:17And so… Kristin Reihman 36:18So, yeah, and typically then we need to get into the ring with those bladder biofilms, and it doesn’t… it doesn’t usually take one or two tests, it’s many tests, because the layers are deep. I’m working with children, too, and even in small kids, they… if they have the right genetics, and if they’re living in an environment that is… that kind of can also push them to make more biofilms, like living in mold, for example, is a huge instigator of inflammation and biofilms, and also, you know, microclots and fibrin in the body. then those layers can go deep. And so, we’re peeling the layers one at a time, and we’re treating what comes out, and supporting people along the way. Dr. Deb 36:57With these microgen tests, can you find biofilms in other parts of the body as well, or is it primarily bladder? Kristin Reihman 37:03No, you can find… you can culture… and you can send a microgen PCR for any… any, you know, secretion you want. So they have a semen test, they have a vaginal test, they have a nasal test, you can send sputum, you can culture out what… you can stick a swab in your ear. There’s all sorts of… anything that you can put a swab in, you can… you can send in there. Oh, that’s awesome, that’s amazing. Yeah. Dr. Deb 37:26So, once you identify the drivers, genetics, environment, stealth infections, what does an effective treatment or reversal process look like for people? Kristin Reihman 37:36For the… for the bladder in particular? Well, I wish I could say it was herbs or oxidation, which are my favorite things for Lyme. I haven’t found those to work for the bladder, and so I’m using antibiotics. Which, even though I’m a Western-trained MD, it was not my bag of tricks. You know, when I left, sort of, the matrix medicine model, I really stopped using those things as much as possible, and I’ve had to come back to them, because they really, really work, and they’re really, really needed. So I love it if someone else out there is getting results with something other than antibiotics, please contact me and let me know, because I have plenty of patients who are like, really? Another antibiotic? I’m like, I know. But they work. We also do a really careful job, you know, I work with Ruth Kriz on every case, and we do a very careful job in finding the drug that’s going to be the least broad spectrum, and that’s really only going to tackle the highest percentage bug there. So, MicroGen does this really cool thing. It’s a PCR, next-gen sequencing, they’re looking at genetics, so you don’t have to have it on ice, it can sit on your countertop for a month, and you can still send it in. And they, they, they categorize by percentage, like, what’s there. And they’re not just looking for the 26 or 28 different bacteria that you would get if you were looking at a culture in your doctor’s office. They’re looking for 57,000 different organisms. Fungal and bacterial, yeah? And so, this is why I say, if there’s something there, and you’ve broken down the biofilm, microgen will find it. Dr. Deb 39:06That’s really great. That was going to be my question, is does it pick up fungal biofilms as well? So I’m so glad you mentioned that, because a lot of times with bladder stuff, it’s fungal in that bladder, too, and then we’re throwing an antibiotic at it and just making it worse if it’s fungal in there. Kristin Reihman 39:21Yeah, yeah, that’s… they… and I recently saw one, I had a little Amish girl who came back with 5 different fungal organisms in her bladder. And a whole flurry, a slurry of bacteria, too. Yeah, pretty sick. And that’s usually an indication that you’re living in mold, honestly. Dr. Deb 39:37Now, conventional medicine treats the bladder as a sterile organ, and rarely looks at biofilms. Why do we believe that this has been overlooked for so long, and what are they missing? Kristin Reihman 39:53Dr. Dr. Deb 39:53I’m loaded up. Kristin Reihman 39:54One of the many mysteries of medicine. I have no idea why people are like, la la la, biofilms. I mean, we know, so when I say we know, so when I trained, you know, I trained at Stanford for my medical school, I trained at Lehigh Valley for residency. Great programs, and I learned that, oh yes, biofilms, they exist in catheters of bladders. When people have an indwelling catheter for more than a month and they spike a fever, it’s a biofilm, but it’s only in the catheter. Really? Why does it stop at the catheter? Dr. Deb 40:23Yeah. Kristin Reihman 40:25Or, you know, now chronic sinusitis, people are recognizing this is a bladder… this is not a bladder, this is a biofilm infection in your sinuses. But we’re really reluctant to kind of admit that there’s, you know, that we’re teeming with microorganisms, that they might be setting up shop, and for good, right? Like, it’d be great if they were in biofilms as opposed to our bloodstream. Like, we don’t want them in our bloodstream, so thankfully they wall themselves off. But yeah, I think they’re everywhere. I mean, they found a microbiome in the brain, in the breast, in the, you know, the lung. There’s microbiome, there’s bugs everywhere. And the question is, are they friend or foe? And the bladder really shouldn’t have anybody in it. Because, think about it, you’re flushing it out, you know, 6 times a day. You know, most people who can break down biofilm because their clotting genetics are normal, and because they’re peeing adequately, will never set up an organism shop in their bladder. Even though things are always crawling up, we’re always peeing them out. Dr. Deb 41:23Yeah. Kristin Reihman 41:23And then there’s the 20% of us who… Who aren’t that way. Dr. Deb 41:30Oh, so you run the Interflow program and a number of healing communities. What tools and teachings have been the most transformational for people going through this journey? And tell us a little bit about the Interflow program, too, please. Kristin Reihman 41:44Okay, maybe I’ll start there, because honestly, I have to think about the which tools are most transformational. The Interflow program is my newest offering, and we developed it because my team and I were looking around at the patients we had, and so many folks were needing to go down this… we call it the microgen journey, like, get on the microgen train and just start that process. And there was just a lot of hand-holding and support, and… education that they were requiring. And by the way, their brains aren’t working that great, because when you have these infections, you know, you’re dealing with, like, downloads of ammonia from time to time from the bladder organisms, you’re dealing with a lot of brain fog, overwhelm, you know, there’s just a lot of… you know how our patients are, they… they… they’re struggling, and they really need a lot of hand-holding, and so we were providing that. But we kept thinking, like, gosh, it would be great to get these guys in community, like you know, we can say all we want, like, you know, it’s important to check your pH, it’s important to, like, stay on top of the whatever, but it’d be great to have them hear that from one another, and to have them also hear, sort of, that they’re not alone. So, because we had some experience running communities online, which we started during the pandemic and has been super successful, we said, let’s do this, let’s create a little online community of our inner… of our, you know, call them… informally, we call them our bladder babes. But, like, let’s create a community of people who are looking to really heal and get to this deep, deep root that no one else is doing. And that was really the key for me, that nobody else is really doing this. Very few people are doing it or aware of it. I wish that weren’t the case, but as it stands now, it’s pretty hard to find someone to take this seriously. Most doctors, if you even take a microgen to them, they’ll say, oh, there’s 10 organisms on here, that’s a contamination. That must be contaminated. Well, yeah, buy your biofilms, but they don’t know about biofilms, so they think it just comes from the lab. Dr. Deb 43:31Something. Kristin Reihman 43:32I don’t know. But, yeah, basically it was because I felt called to do this service that no one else is providing, and I wanted to do it in a way that was going to be really optimally supportive for people. So we created a membership, basically. Dr. Deb 43:44Do you see a difference in men and women? Obviously, women have this problem more than men, but do you see a difference in how many men that have these self-infections or live in mold compared to women? Kristin Reihman 43:57I… it’s hard to know, really, what the, sort of, prevalence is out there, I will say, in terms of who calls our office. Dr. Deb 43:03It’s, you know, 95% women call our office. Kristin Reihman 44:08And occasionally, we’ve had someone call our office on behalf of a husband or a son. I just saw a woman whose 2-year-old son is in our Bladder Babes community. But typically, it’s the women who are seeking care around this, and I don’t know if that’s a function of their having more of the issues. I suspect it is, because as you said before, so many more women deal with these complex mystery illnesses than men.But there certainly are men who have them. Dr. Deb 44:33Yeah. So, you’ve lived through Lyme, chronic illness, stroke, and now biofilm-driven bladder issues, and you’ve come out stronger. What mind shifts helped you stay resilient through all of these chapters? Kristin Reihman 44:50I think there have been many. I think the first one I had to really, Really accept and lean into and kind of internalize. Was this idea that, I… I couldn’t… I didn’t have to do the work that I was doing. Dr. Deb 45:09You know? Kristin Reihman 45:09In order to be of value to the world. You know, I’d trained in a certain way, I had, you know, I had this beautiful practice. I was working in the inner city, I was working with my best friend, we were seeing really needy people who had no money, and it felt really, like, you know, I felt very sort of service-driven and connected to a purpose. And I think the hardest thing in the beginning for me was realizing, I can’t do that work anymore. That’s not the work that I’m… needing to do, and to make a leap into the unknown. It felt like, you know, having a baby at 45 and not doing any ultrasounds, or any tests, and just being like, I’m birthing something here. I don’t know what it is, it’s me, but who knows what she’s gonna look like, or… what this doctor is going to be, you know, what, you know, peddling in terms of her tools. That was a big leap of faith, and I think letting go of the kind of control of needing to be… needing to look a certain way and be a certain kind of doctor was a big step for me, my big initial step. Dr. Deb 46:05That’s really hard, because you’re taught and ingrained in who you’re supposed to be as a doctor, and what that person’s supposed to be, what your persona’s supposed to be. And doing a lot of the Klinghart work and some of those things, and I’m sure on the days crawling through the floor, you’re like, this is not what I was trained to do. If my colleagues could only see me now, they’d… they’d… Commit me, right? But like you said, just giving that leap of faith and saying, I’m gonna turn this over to your higher power, and you’re gonna bring me out on the other side, and trusting that, that is a vulnerability for us that is huge. Kristin Reihman 46:43Yeah, and I mean, I’d like to say it’s because I’m some sort of strong person, but truthfully, I feel like there was no other choice. Like, I had to surrender because there was… the alternative was death or something. I didn’t… I don’t know, right? There was no other choice. Dr. Deb 46:56Yeah. Kristin Reihman 46:56I couldn’t move. I was in so much pain. I couldn’t move. Couldn’t get out of bed. Dr. Deb 47:01Thank you so much for sharing all of this and being vulnerable with our audience. Where can people find you? Find your book, your podcast, your programs, if they want to go deeper with you? Kristin Reihman 47:12Yeah, thanks for asking. So, I have a website, it’s my name, kristenRymanMD.com, and all my programs are listed there. I have several, you know, I have a, sort of, a wellness… I have an online membership for well people who want to stay well and pick my brain every week around, sort of, healthy, holistic tools. It’s called The Healing Grove.I have a podcast that people can listen to for free, where I interview people like you, and you’re gonna be on it, right? She’s gonna be on it soon. Dr. Deb 47:38I’d love to. Kristin Reihman 47:39So I can share stories of hope and transformational tools with people. I also have a Life After Lyme coaching program, which is kind of the place where I invite people who are dealing with a mystery illness to come get some support, community, and guidance from someone like me, and also just from the other people in the room. There’s a lot of wisdom in those groups. And that’s… I guess that’s the answer I’ll share for what you asked earlier, like, what’s the main tool they take away? I think they take away an understanding that community really matters, and that they’re not alone. You know, I think it can be very lonely to be stuck in these… to feel stuck in these illnesses, and people need to be reminded that they’re… that they’re human, you know, and that they’re worthy of love and acceptance. I think that’s what people get from my… from my community, is kind of like, that’s the common thread. Dr. Deb 48:23They definitely need that. Kristin Reihman 48:25Man. Dr. Deb 48:26Kirsten, thank you so much for sharing your powerful story. Your work is so needed, and your ability to weave personal experience and advanced clinical insight is exactly what our community craves. And this kind of conversation helps women finally be seen and heard, which is my motto too, and gives them just the real tools to get their life back. And for everyone listening, if you’re struggling with unexplained bladder pain, frequent UTIs, pelvic discomfort, or symptoms that never match your labs, because they never quite do. You are not crazy, you are not alone. You need to find the answers, you need to be with community, and there are solutions, and conversations like this is how we bring them forward. So, thank you all for tuning in to Let’s Talk Wellness Now. I’m your host.And until next time… Kristin Reihman 49:15Thanks, Dr. Dove. Dr. Deb 49:16Thank you. This was awesome. Thank you so much. This was… Kristin Reihman 49:21You’re so welcome, you’re such a great interviewer.The post Episode 251 – Chronic Bladder Symptoms, Biofilms, and the Hidden Genetic Drivers first appeared on Let's Talk Wellness Now.
Episode 546: When the Brain Pathobiome Becomes Personal: Polymicrobial Drivers of Cognitive Decline – Nicole Bell
Overview This special episode of the Tick Boot Camp Podcast was recorded live at the 2nd Annual Alzheimer's Pathobiome Initiative (AlzPI) and PCOM Symposium in collaboration with Pathobiome Perspectives. Hosted by Ali Moresco in partnership with Nikki Schultek (Executive Director, AlzPI), the conversation advances the Tick Boot Camp mission of exploring infection-associated chronic illness (IACI)—including Lyme disease and other tick-borne infections—within the global Alzheimer's and neuroimmunology community. Tick Boot Camp co-founders Matt Sabatello and Rich Johannesen partnered with Ali and Nikki to amplify voices connecting tick-borne illness, microbes, and cognitive decline. This episode features Nicole Bell—author, entrepreneur, and CEO of Galaxy Diagnostics—whose memoir What Lurks in the Woods documents her late husband Russ's misdiagnosed tick-borne illness and their search for answers. Guest Nicole Bell Author of What Lurks in the Woods CEO, Galaxy Diagnostics Advocate for tick-borne and neurodegenerative disease BS/MS, Materials Science & Engineering (MIT) MS, Biomedical Engineering (Duke University) At the Symposium, Nicole presented “When the brain pathobiome becomes personal,” sharing her family's journey and new findings from Russ's donated brain: laboratory evidence of Borrelia burgdorferi, Chlamydia pneumoniae, and Babesia otocoli (a species long thought to be deer-restricted) in brain tissue—data now being prepared for publication. Researchers also noted elevated heavy metals (lead, mercury), underscoring how polymicrobial infection plus toxic exposures may converge to drive neuroinflammation and Alzheimer's-like decline. Key Discussion Points Nicole details how repeated “normal” neurology workups masked a complex pathobiome process. She explains why standard two-tier Lyme serology can miss true infection, how direct detection can change care, and why patients should consider Bartonella and Babesia alongside Lyme. She outlines hallmark Bartonella clues—including striæ that resemble stretch marks (often more visible after hot showers), neuropsychiatric manifestations (irritability, anxiety, OCD, tics), ocular and joint involvement—and highlights non-tick vectors (notably fleas and household cats) that expand risk beyond forest exposure. Nicole advocates for building a diagnostic toolkit that combines serology with sensitive direct tests to clarify which pathogens are active—critical because Borrelia, Bartonella, and Babesia require different treatment paradigms. Looking forward, she envisions comprehensive screening panels for midlife cognitive changes that integrate pathogen load, host immune signatures, and toxin status, enabling earlier, targeted interventions. “Everyone wants a simple A→B. But the toughest chronic conditions are subtle and multifactorial. Accurate data, direct detection, and a clinician who will go on the journey with you can change everything.” — Nicole Bell Why It Matters Nicole's story humanizes the science: polymicrobial infection + toxins + host factors can look “psychiatric” or “idiopathic” until modern testing reveals the underlying pathobiome. Her advocacy pushes medicine toward precision diagnostics, earlier detection, and pathogen-informed care that may prevent years of decline. About the Event Recorded at the 2nd Annual Alzheimer's Pathobiome Initiative (AlzPI) and Philadelphia College of Osteopathic Medicine (PCOM) Symposium on October 3, 2025, at Ohio University (Dublin, Ohio). The meeting convened global experts investigating how microbes, the microbiome, and immune responses contribute to Alzheimer's, dementia, PANS/PANDAS, and other infection-associated chronic illnesses (IACI). This episode is part of a Tick Boot Camp series connecting chronic Lyme research with cutting-edge brain-immune science. Learn More Learn more about the Alzheimer's Pathobiome Initiative (AlzPI) Listen to Tick Boot Camp Podcast episodes, including Episode 406: Pathobiome – An Interview with Nikki Schultek, Episode 101: The Young Gun – An Interview with Alex (Ali) Moresco, and Episode 216: What Lurks in the Woods – an interview with Nicole Bell discussed in this interview.
The Complexity of Lyme: Testing, Treatments, and Strategies with Dr. Steven Harris
In this episode of Integrative Lyme Solutions with Dr. Karlfeldt, Dr. Michael Karlfeldt is joined by Dr. Steven Harris, an expert in Lyme disease. They discuss the complexities of diagnosing and treating Lyme disease, co-infections, and the significance of understanding the immune response. Dr. Harris shares insights into advanced diagnostic testing, including immuno blot, PCR, and T-cell testing. He also explains the importance of clinical diagnosis in Lyme disease and the roles of various co-infections such as Babesia, Bartonella, and Anaplasma. The episode provides an in-depth look at how modern technology and methodologies are improving the accuracy and effectiveness of Lyme disease treatment. 04:15 Current State of Lyme Testing 10:47 Advanced Testing Techniques 18:03 Strategies for Accurate Diagnosis 25:40 Frustrations and Rewards in Lyme Treatment 35:50 T-Cell Testing and Its Benefits 43:16 Co-Infections and Their Symptoms 47:57 Conclusion and Final Thoughts --------------- The Karlfeldt Center offers the most cutting-edge and comprehensive Lyme therapies. To schedule a Free 15-Minute Discovery Call with a Lyme Literate Naturopathic Doctor at The Karlfeldt Center, call 208-338-8902 or email info@TheKarlfeldtCenter.com Check out Dr. K's Ebook: Breaking Free From Lyme: A Comprehensive Guide to Healing and Recovery here: https://store.thekarlfeldtcenter.com/products/breaking-free-from-lyme You can purchase it for $24.99 or use the code LYMEPODCAST for a 100% off discount! _______________________________The Karlfeldt Center offers the most cutting-edge and comprehensive Lyme therapies. To schedule a Free 15-Minute Discovery Call with a Lyme Literate Naturopathic Doctor at The Karlfeldt Center, call 208-338-8902 or email info@TheKarlfeldtCenter.comCheck out Dr. K's Ebook: Breaking Free From Lyme: A Comprehensive Guide to Healing and Recovery here: https://store.thekarlfeldtcenter.com/products/breaking-free-from-lymeUse the code LYMEPODCAST for a 100% off discount!
Episode 544: How Microbes Like Lyme May Trigger Alzheimer's and Cognitive Decline – Dr. Brian Balin (PCOM)
Overview This special episode of the Tick Boot Camp Podcast was recorded live at the 2nd Annual Alzheimer's Pathobiome Initiative (AlzPI) and PCOM Symposium in collaboration with Pathobiome Perspectives. Hosted by Ali Moresco in partnership with Nikki Schultek, Executive Director of AlzPI, the conversation brings the Tick Boot Camp mission of exploring infection-associated chronic illness (IACI), like Lyme disease and other tick-borne diseases, to the global Alzheimer's and neuroimmunology research community. Tick Boot Camp co-founders Matt Sabatello and Rich Johannesen partnered with Ali and Nikki to highlight scientists whose work connects tick-borne illness, microbes, and cognitive decline. This episode features Dr. Brian J. Balin, an internationally recognized neuroscientist whose research has redefined the role of infection in contributing to Alzheimer's disease. Guest Brian J. Balin, PhD Professor of Neuroscience and Neuropathology Director, Center for Chronic Disorders of Aging Philadelphia College of Osteopathic Medicine (PCOM) Dr. Balin directs the Center for Chronic Disorders of Aging and the Adolph and Rose Levis Foundation Laboratory for Alzheimer's Disease Research at PCOM. With a PhD from the University of Maryland School of Medicine and postdoctoral training at the University of Pennsylvania, he has devoted nearly three decades to understanding how chronic infection and inflammation trigger neurodegeneration. His pioneering discovery that the respiratory bacterium Chlamydia pneumoniae infects brain tissue helped establish the Pathogen Hypothesis of Alzheimer's disease. His continuing work explores how tick-borne microbes — including Borrelia burgdorferi (Lyme disease), Bartonella, and Babesia — interact with other pathogens to drive neuroinflammation and cognitive decline. Key Discussion Points How infections such as Chlamydia pneumoniae, Borrelia burgdorferi, Bartonella, and Babesia were detected in Alzheimer's brain tissue. Evidence that microbes can enter the brain via the olfactory pathway or blood-brain barrier, initiating chronic inflammation, amyloid plaque formation, and tau tangle pathology. Findings from Dr. Balin's collaboration with Galaxy Diagnostics and advocate Nicole Bell, revealing polymicrobial infection and even Babesia otocoli — a strain previously believed to infect only deer — in human brain tissue. The use of animal models and 3D human brain organoids to study infection-driven neurodegeneration. Why identifying infection as part of the exposome (environmental insults over a lifetime) is key to developing precision diagnostics and treatments. Future directions: immune-modulating drugs, antimicrobials, and emerging phage therapy. “Infection is part of the exposome — an environmental insult that shapes our health over a lifetime. Recognizing that is key to truly understanding and preventing Alzheimer's disease.” — Dr. Brian J. Balin Why It Matters Dr. Balin's research bridges the worlds of neurology and infectious disease, offering a framework that could revolutionize how Alzheimer's and other neurodegenerative conditions are diagnosed and treated. By recognizing that microbes — including those transmitted by ticks — can initiate neuroinflammation and cognitive decline, his work provides hope for millions living with infection-associated chronic illness. About the Event The interview took place at the 2nd Annual Alzheimer's Pathobiome Initiative (AlzPI) and Philadelphia College of Osteopathic Medicine (PCOM) Symposium, October 3, 2025, Ohio University in Dublin, Ohio. The Symposium brought together more than 20 experts exploring how microbes, the microbiome, and the host immune response contribute to neurological and psychiatric diseases such as Alzheimer's, dementia, and PANS/PANDAS. Tick Boot Camp partnered with Ali Moresco and Nikki Schultek to document and share the voices of scientists advancing research on infection-associated chronic illness (IACI). This episode is part of a special series showcasing how pathobiome and microbiome science is changing our understanding of chronic Lyme and neurodegenerative disease. Learn More Learn about the Alzheimer's Pathobiome Initiative (AlzPI) at AlzPI.org. For Dr. Balin's publications and ongoing research, visit the Philadelphia College of Osteopathic Medicine (PCOM) website. Learn more about the Alzheimer's Pathobiome Initiative (AlzPI) Listen to Tick Boot Camp Podcast episodes, including Episode 406: Pathobiome – An Interview with Nikki Schultek and Episode 101: The Young Gun – An Interview with Alex (Ali) Moresco discussed in this interview.
301
In this powerful episode, Wendy Valentine sits down with Nicole Bell, author of What Lurks in the Woods and CEO of Galaxy Diagnostics, to uncover the truth about Lyme disease and tick-borne infections that are too often misdiagnosed or misunderstood. Nicole shares her deeply personal story of her husband's tragic battle with a misdiagnosed tick-borne illness that was mistaken for early-onset Alzheimer's, and how that journey fueled her mission to transform Lyme testing and awareness. Together, Wendy and Nicole discuss why so many people struggle to get answers, the importance of early detection, the connection between Lyme, chronic illness, and hormone shifts, and how to become your own best health advocate. What You'll Learn: Why Lyme disease is often misdiagnosed and misunderstood The difference between Lyme and other tick-borne infections like Babesia and Bartonella How traditional Lyme testing fails—and what new diagnostic methods work better Common symptoms that can mimic menopause, anxiety, or chronic fatigue How tick-borne illness can trigger neurodegenerative and mental health conditions Practical steps to protect yourself, detect infection early, and find real healing
Episode 542: Z3LLA - Using Lyme Disease to Redefine Resilience in the Music Industry
In this powerful episode of the Tick Boot Camp Podcast, international DJ and artist duo Z3LLA — Julia “Juj” Seeley and Kiana Tebyani — share how chronic illness, creativity, and friendship became the foundation of their success. After years of unexplained symptoms, Juj was diagnosed with Lyme disease, Bartonella, Babesia, mold toxicity, POTS, SIBO, celiac disease, and later catamenial epilepsy. Despite life-altering health challenges, she and her best friend Kiana have built Z3LLA into one of the most exciting names in house music — with their single “Why Should I?” reaching #1 on the US Dance Radio Charts and performances alongside Disco Lines, Galantis, and Bijou. Together, Juj and Kiana discuss performing through flare-ups, collapsing backstage, navigating the medical system, and the emotional toll of chasing dreams while managing invisible illness. From ER visits and red-light therapy to steroid crashes and spiritual breakthroughs, this episode is a masterclass in resilience, vulnerability, and using art as advocacy.
Episode 540: Dr. Bill Rawls on Chronic Lyme, Herbs, Gut Health, and Stepwise Recovery at Project Lab Coat, New York Fashion Week
Recorded in person in Central Park, NYC just before Project Lab Coat at New York Fashion Week (NYFW), this Tick Boot Camp Podcast features Dr. Bill Rawls on what helps chronic Lyme patients move from overwhelm to progress. We talk immune-first strategy, why antibiotics often fall short in chronic cases, how to protect the gut, and a stepwise plan that reduces flare risk and builds confidence. Episode snapshot Dr. Rawls explains why stealth microbes like Borrelia, Bartonella, and Babesia grow slowly and hide in tissues, which is why a quick-fix antibiotic approach often disappoints in chronic illness. We discuss a four-phase healing framework — prehabilitation, assist the immune system, rehabilitation, and maintenance (PARM) — and how a gradual, system-calming on-ramp helps patients tolerate protocols without crashing. We also dig into gut protection, community support, and how AI can speed education and research. What you will learn Why “assist the immune system” beats “kill at all costs” for chronic Lyme Stealth microbe biology and why slow growth changes the treatment playbook Antibiotic overuse risks including microbiome injury and antibiotic resistance Gut and detox support as foundations for energy, sleep, and resilience A stepwise entry to treatment that reduces flares and anxiety Key herbs with evidence for tick-borne infections and immune modulation Community and education as levers for consistency and long-term success How AI tools can accelerate research, writing, and practical guidance Key topics and takeaways Four phases of recovery: prehab, assist, rehab, maintenance Antibiotics in chronic Lyme: may disrupt the gut before meaningfully impacting slow-growing pathogens Herbal strategy: sustained pressure over time with immune support Gradual on-ramp: calm the nervous system first, then gut and detox, then stronger antimicrobials Team sport: combine self-care, educated use of providers, and moderated community support Herbs and supports mentioned Antimicrobial herbs: Japanese knotweed, Chinese skullcap, Cryptolepis, cat's claw, garlic Immune-modulating adaptogens: reishi, cordyceps Supportive nutrients: B vitamins, minerals, NAC, glutathione Formats: capsules and tinctures were discussed, including products like Advanced Biotic and Biome Boost within larger protocols Patient-friendly pacing Months 1–2: calm sympathetic overdrive, improve sleep, stabilize Months 3–4: protect gut, support detox, keep gentle antimicrobial pressure Months 5–6: advance to stronger combinations when the body is ready Ongoing: measure progress, maintain gain, prevent backsliding Notable quotes “The immune system always wins the game. Your job is to assist it.” “Stealth microbes grow slowly and hide in tissues. The strategy has to match the biology.” “Education and a supportive community reduce fear and make consistency possible.” Resources and links Watch the video version of this podcast interview on YouTube Read our NYFW Recap: Tick Boot Camp models at Project Labcoat and Why it Matters for Lyme Awareness, Research, and Funding
Episode 539: Geoff Dow on Babesiosis: Malaria Parallels, Tafenoquine (Arakoda), and New Clinical Trials for Chronic Tick-Borne Disease
Dr. Geoff Dow, CEO of 60 Degrees Pharmaceuticals and former malaria drug developer at Walter Reed, joins the Tick Boot Camp Podcast to unpack the science and strategy behind treating babesiosis. Drawing parallels to malaria, Dow explains why tafenoquine (brand: Arakoda), FDA-approved for malaria prevention, is being studied for Babesia, how coinfections (Borrelia, Bartonella) complicate care, and why chronic illness needs a different clinical approach. He previews an upcoming Mount Sinai trial for chronic babesiosis focused on fatigue outcomes and discusses real-world diagnostics using FDA-approved blood donor screening plus PCRs from Galaxy Diagnostics and Mayo Clinic. The conversation also touches on prophylaxis concepts, immune dysregulation, and building a clearer path from anecdote to evidence for the tick-borne disease community. Guest Geoff Dow, BSc, MBA, PhD CEO & Board Member, 60 Degrees Pharmaceuticals Background: Biotechnology (Perth, Australia), PhD in malaria drug discovery, decade at Walter Reed Army Institute of Research, MBA in the U.S. Leads clinical programs exploring tafenoquine for babesiosis. Key Topics & Takeaways Malaria ↔ Babesiosis Parallels: Both are red-blood-cell parasites; acute symptoms driven by red cell destruction. Similar drug targets justify testing some anti-malarials against Babesia. Why Tafenoquine (Arakoda): An 8-aminoquinoline that induces oxidative stress in RBCs; distinct mechanism from atovaquone + azithromycin combo (current standard for acute babesiosis), potentially useful for resistance management. Chronic vs. Acute Disease: Acute babesiosis in immunocompetent patients often responds to standard care; chronic illness remains under-defined and underserved. Coinfections Are Common: Many chronically ill patients present with Borrelia, Bartonella, and Babesia together; diagnostics and treatment need to acknowledge polymicrobial reality. Upcoming Clinical Trial (Mount Sinai): Population: Chronic babesiosis with disabling fatigue, plus Babesia symptoms (e.g., air hunger, anemia) and lab evidence in the last 12 months. Regimen: 4-day loading dose then 200 mg weekly of tafenoquine for 3 months. Outcomes: Patient-reported fatigue (quality-of-life) + monthly molecular testing (FDA blood donor test, Galaxy Diagnostics PCR, Mayo Clinic PCR) during treatment and 3 months post-therapy. Goals: Demonstrate symptom improvement, assess eradication signals, and validate accessible diagnostics against an FDA-accepted assay. Prophylaxis & Post-Exposure Ideas: Animal data suggest short-course tafenoquine can eradicate early Babesia; human prophylaxis trials face feasibility and regulatory hurdles. Diagnostics Gap: Need for standardized, sensitive tools to define chronic babesiosis and track response. This trial also serves as a real-world diagnostic comparison. Immune Dysregulation & IACI: Overlap among long COVID, ME/CFS, post-treatment Lyme—shared theme of immune dysregulation with possible persistent antigen stimulation. Safety Notes: G6PD deficiency is relevant to 8-aminoquinolines; established safety database exists for malaria prevention dosing—critical as studies expand to babesiosis. Notable Quotes “You've got to put some lines in the sand—run the trial, collect data, and move the field forward.” “The best we can do for chronic disease starts with defining it—and validating the diagnostics we use to track it.” “8-aminoquinolines offer a different mechanism than current babesiosis standards—key for resistance and combinations.” Resources Mentioned Arakoda (tafenoquine): FDA-approved for malaria prevention; under study for babesiosis. Diagnostics: FDA-approved Babesia blood donor screen; Galaxy Diagnostics PCR; Mayo Clinic PCR. Organizations & Events: ILADS, Global Lyme Alliance, tick-borne disease conferences. Research Partners: Mount Sinai (NYC), Tulane University (Bartonella/Borrelia collaboration). Who Should Listen Patients with chronic Lyme or chronic babesiosis symptoms (fatigue, air hunger, anemia) Clinicians seeking updates on Babesia treatment research and diagnostics Caregivers and advocates tracking IACI and immune dysregulation science Researchers exploring antimalarial repurposing for tick-borne diseases Call to Action Subscribe to Tick Boot Camp and share this episode with someone navigating chronic tick-borne illness.
Dr. Jyotsna Shah is an immunologist and molecular biologist with over 40 years of experience in diagnostic tools for tick-borne diseases. She holds a Ph.D. in diagnostic immunology from the University of Nairobi and conducted postdoctoral work at Harvard University. Shah joined IGeneX in 1997, becoming Laboratory Director in 2003 and now serving as President and CEO.
Lyme Disease Exposed: Breaking Down Misdiagnoses and Innovations, Part 1
This episode of the Intelligent Medicine podcast is a deep dive into the complexities of Lyme disease and other tick-borne illnesses. Nicole Bell, the CEO of Galaxy Diagnostics and author of “What Lurks in the Woods,” details the challenges of diagnosing tick-borne diseases, the limitations of current diagnostic tests, and the controversy around treatment methodologies. Nicole shares her personal journey that led her to this field after her husband was misdiagnosed with early-onset Alzheimer's, which was later revealed to be caused by advanced Lyme disease. They also discuss new diagnostic techniques, the importance of personalized treatment plans, and ongoing advocacy efforts to improve awareness and research funding for Lyme disease.
Lyme Disease Exposed: Breaking Down Misdiagnoses and Innovations, Part 2
Dr. Hoffman continues his conversation with Nicole Bell, the CEO of Galaxy Diagnostics and author of “What Lurks in the Woods.”
Air Hunger, FDA Thyroid Controversy, Peptides, PCOS & Mold | Ask Me Anything
In this special Ask Me Anything episode of The Art of Being Well, Dr. Will Cole and his telehealth team dig into your most urgent health questions. From the hidden causes of air hunger and why it worsens with mold, Lyme, or Babesia, to the FDA's controversial move against natural thyroid medications, nothing is off limits. They also explore how functional medicine approaches PCOS in teenagers, and why cutting-edge peptides like retatrutide are generating both excitement and caution. As always, Dr. Cole offers practical, root-cause answers for navigating complex conditions with clarity and hope. For all links mentioned in this episode, visit www.drwillcole.com/podcast.Please note that this episode may contain paid endorsements and advertisements for products and services. Individuals on the show may have a direct or indirect financial interest in products or services referred to in this episode.Sponsors:Go to Quince.com/willcole for free shipping on your order and three hundred and sixty-five-day returns.Sign up for your one-dollar-per-month trial and start selling today at SHOPIFY.COM/willcole.Go to shopremi.com/WILLCOLE and use code WILLCOLE at checkout for 50% off.You can get an additional 15% off their 90-day subscription Starter Kit by going to fatty15.com/WILLCOLE and using code WILLCOLE at checkout.Use my link to give the new AG1 flavors a try, plus a FREE Welcome Kit: drinkag1.com/willcole. Produced by Dear Media.See Privacy Policy at https://art19.com/privacy and California Privacy Notice at https://art19.com/privacy#do-not-sell-my-info.
980 - Expert Reveals Signs You Have Parasites (And How to Treat)
Today I'm excited to have board-certified internist and complex chronic disease expert, Dr. Tania Dempsey back on the podcast to discuss parasites. Hidden parasites are more common than you think and may even be related to conditions such as SIBO, IBS, Histamine intolerance and poor immune system health. We'll cover the types of parasites, best testing options, a treatment protocol and how to prevent parasites. You don't want to miss this! Start healing with us! Learn more about our virtual clinic: https://drruscio.com/virtual-clinic/ Follow Dr. Tania Dempsey https://drtaniadempsey.com/about/ https://drtaniadempsey.com/podcast/ https://www.instagram.com/drtaniadempseymd/ https://www.youtube.com/@DrTaniaDempsey https://www.facebook.com/taniadempseymd/































